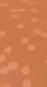

CELEBRATE WOMEN IN THE INDUSTRY

Inline Plastics Expands Safe-T-Chef® Line
ELEVATE FOODSERVICE QUALITY WITH NOVIPAX
Ajinomoto Health & Nutrition EAT WELL, LIVE WELL







LAUNCHES
Lightly Smoked







Chef is


















































Chasing Flavor Carla Hall


INDUSTRY LEADERS • TRENDS • BEVERAGE • CUISINE • CHEF • RESTAURANT • HOSPITALITY


the newest release from michael david winery now available nation wide
















COVER IMAGE
Chef Carla Hall
Image Credit: Max
PUBLISHER
MICHAEL POLITZ Michael@fb101.com
DIRECTOR & EDITOR-IN-CHIEF
LAUREN KANE Lauren.Kane@fbmagazine.com
SOCIAL MEDIA CONTENT MANAGER
SHELBY POLITZ Shelby.Politz@fbmagazine.co
DIRECTOR OF PROGRAMMATIC SALES BARB ROGERS Programmatic@fbmagazine.com
ACCOUNT MANAGERS
LENORE O’MEARA Lenore.Omeara@fbmagazine.co
DAVID JACOBS David.Jacobs@fbmagazine.co
AUSTIN VALDEZ Austin.Valdez@fbmagazine.co
SUSAN GOLD Susan.Gold@fbmagazine.com
CONTRIBUTING EDITORS
MICHAEL POLITZ
STEPHANIE BLITZ
CONTRIBUTING WRITERS
LAUREN MCINDOO
LENORE O’MEARA
DAVID JACOBS
SUSAN GOLD
SHELBY POLITZ
ETHAN BALSAMO
AUSTIN VALDEZ
RYAN SLATTERY
We honor and remember the support of Chef Kerry Simon, Gary Cantor, Robin Leach, Chef Paul Prudhomme, & Gary Coles
2024
MARCH ISSUE
Food & Beverage Magazine® is owned and published electronically by Beautiful People, LLC. Copyright 1995-2016 Beautiful People LLC. All rights reserved. Food & Beverage Magazine® and distinctive logo are trademarks owned by Beautiful People, LLC. “fb101.com” is a trademark of Beautiful People, LLC. No part of this electronic magazine may be reproduced without the written consent of Food & Beverage Magazine. Requests for permission should be directed to: Lauren.Kane@fbmagazine.com. The information contained has been provided by such individual, event organizers or organizations. The opinion expressed in each article is the opinion of its author, organization or public relation firm. Food & Beverage Magazine is not affiliated with any other food and beverage or hospitality publication.

Page 5 Celeb Cover Feature
Page 17 Industry News
Page 21 Spirits
Page 25 Hospitality News
Page 33 Spirit News
Page 35 Industry Leaders
Page 39 Spirit News
Page 41 Hospitality News
Carla Hall
Women Driving Growth & Creative Development
Changing the Way People Think About Whiskey
Shining a spotlight on the leading ladies in the industry
Cardinal du Four
Elevate Food Service Quality with Novipax
National Espresso Martini Day!
Notable Women Making Honorable Contributions
Page 3 | Food & Beverage Magazine v March Issue 2024
Contents March 2024
PAGE 5
Inside this issue COVER FEATURE

Page 45 Industry Leaders Precision Fermentation Provides Nutrition Without Compromise
Page 49 Spirits News BeatBox Green Apple
Page 53 Industry Leaders Inline Plastics: Anti-Fog Technology
Page 57 Industry Tips
Les Dames d’Escofer | Kersten Rettig
Page 59 Editor’s Top Pick: Minority-Owned Products
Page 85 Brand Cover Ducktrap

PAGE 85

PAGE 35
PAGE 21


PAGE 53
March Issue 2024 v Food & Beverage Magazine | Page 4


BEHIND EVERY FOOD IS A STORY WAITING TO BE FOUND
Carla Hall is a celebrated chef, Food Network personality, and awardwinning author who also happens to genuinely enjoy getting to know people. Instead of asking how a person was doing, Chef Hall made a conscious effort to come up with a more meaningful question. Upon meeting someone new, she would ask them to tell her about their favorite dish. Immediately, their eyes would light up as they shared a detailed account of their favorite food and the memories it brought back to life. It was this vested interest in hearing the stories of strangers that led to the creation of Chasing Flavor, a six-episode Max original television series that premiered on February 1, 2024. As the host and executive producer, Chef Hall travels across the world literally chasing down the origins and history of America’s most beloved foods. We’re talking ice cream, hot chicken, tacos, and more!
“I think my love of people is part of my superpower, alongside my fascination with culture and its impact on the culinary world,” said Chef Hall. “It’s always been important for me to get a true insight into something that is close and meaningful to a person who lives somewhere else versus my version of their culture and the way in which I’ve experienced it.”
Page 7 | Food & Beverage Magazine v March Issue 2024

March Issue 2024 v Food & Beverage Magazine | Page 8
Chef Hall’s curiosity and commitment to seeing the bigger picture comes through in each episode as the viewer is given a more complete perspective of classic dishes, revealing the history one layer at a time. Going beyond recipes, Chasing Flavor shares personal narratives that were always meant to be shared but got lost along the way. This is due in large part to the fact that when cultures move, they are often forced to adapt their particular way of doing things — or in this case, cooking things — based on what’s available. When it comes to recipes that have been passed on for generations, adaptations are inevitable but that doesn’t mean the original essence of the food is lost. The transformations happen organically and can still pay homage to its original version. It truly is a butterfly effect. The challenge lies in making a concerted effort not to forget or lose sight of the importance of taking the time to uncover that origin story.
“There may be a dish that’s part of your culture that goes back hundreds or thousands of years,” said Chef Hall. “You only know a piece of that history, yet you still hold onto that part of the story and your connection to it. I’m asking people to recognize that this
food is a living, breathing thing that can be changed but also honored.”
Chef Hall’s travels for Chasing Flavor took her on a journey with unexpected discoveries, emotional connections, and personal revelations. In one of the six episodes, she meets the Black family that served the first hot chicken in
1980, gave an intimate look at how she and her family are holding onto their recipe and legacy. This is just one example of how the show represents so many voices while reinforcing the way in which dishes and recipes travel. Chasing Flavor is about ensuring originators get credit for their culinary creations and at the same time, helping people to see that food is fluid. There is an undeniable cultural connection to a recipe, but it also comes from countless other influences.
on Chef Hall. She didn’t grow up eating authentic tacos, which allowed Chef Hall to remain open minded as the story unfolded. This led to a surprising connection between food and language. As soon as you hear the word “taco” people have an idea of what they’re going to get — some type of protein in a shell type carrier with

salsa. This was Chef Hall’s aha moment, as she clearly understood how language plays a pivotal part in how food travels.
“When it comes to soul food and the lack of our language through the African diaspora, a lot of the contributions from the enslaved people to American food gets lost and muddied,” said Chef Hall. “As a result, soul food has assimilated into the American culinary culture with an unclear picture of the roots from which it came.”
This makes it all the more important to uncover the missing links to these origin stories. The process for finding the right recipes and people to feature involved a lot of time and digging into the details. Speaking to a number of different individuals to ensure the details aligned was a pivotal part of the equation. The integrity of information received and portrayed in Chasing Flavor remained a top priority from day one. Filming began at the end of 2021 and regulations and the research itself, it was a process that took a lot of patience, passion and persistence.
One dish Chef Hall knew she wanted to feature was chicken pot pie, which has played a significant role in her personal food journey. Following the recipe culinary creations she made that felt chef-like. When she appeared on Top Chef, her winning dish was none other than chicken pot pie. It was also a recipe included in Chef Hall’s first cookbook, Cooking with sense that it would make an appearance in one of the episodes in Chef Hall’s debut docuseries — and it did not disappoint. From England to Rome to twists and turns in the chicken pot pie narrative.


COOKING WITH CURIOSITY
Hall didn’t begin her career as a chef. In fact, she was was piqued. She found herself attending many Sunday brunches where Americans and expats were cooking delicious dishes and telling the stories that went along with them. It got Hall thinking about what her stories would be. So she began cooking for the people she was living with as an act of gratitude and later, started a lunch delivery service that lasted for five years. Before attending culinary school, Chef Hall was self-taught, relying on cookbook magazines near the checkout in grocery stores and her own determination to refine her food-making skills while getting a better understanding of her connection to certain recipes.
“I didn’t start cooking until I was in my mid-twenties and many of my food memories revolved around the dishes my mother made, which were not very sophisticated — like Hamburger Helper and Rice-A Roni,” said Chef Hall. “However, when I accepted soul food as the connection to my culture and began using the techniques I obtained from culinary school to recreate recipes from my childhood, I was able to feel
closer to both my grandmothers (who were amazing cooks), even though they had both passed.”
Chef Hall has always been fascinated with the way food plays such a pivotal role in people’s lives. Food is a multifaceted experience that involves taste, smell, sight, sound. surround you at the table. It’s present while on vacation or at a work conference. It’s a part of celebrations and grievances. Throughout the course of our lifetime, there are always instances where food has the ability to pull you in or take you back to a particular moment. Filming Chasing Flavor allowed Chef Hall to delve deeper into the diverse influences certain foods have had on American cuisine.
Chef Hall feels so blessed to have worked with the talented film crew and production team and to have met the amazing people who were willing to share their stories. Everyone involved knew Chasing Flavor was something incredibly special and after waiting a very long two years, people are finally getting to see it! As the viewers come with Chef Hall, uncovering the many facets behind each featured food, the hope is that they become curious about other dishes they enjoy or make themselves. On a

Page 11 | Food & Beverage Magazine v March Issue 2024

practical level, people who watch the show are likely to be inspired to find restaurants and food experiences within their community that offer the dishes featured in each episode. And taking things one step further by getting to know the people serving them and their stories.
“In creating Chasing Flavor, I envision people will have a greater desire to discover the history behind the foods they eat,” said Chef Hall. “To find ways they can honor the stories of their culture or traditions while realizing that food is a living, breathing thing that is constantly transforming.”
At the end of the day, it’s important to recognize that we are all a part of a narrative that is carried on from generation to generation through food. And like the title, Chasing Flavor, we act as a present participle, continuously impacting the way in which we experience the dishes that help to define us.
Sit back, relax and get a taste of the history behind some of your favorite recipes when you watch Chasing Flavor on Max. Click here for episodes.
her website, Food Network and @carlaphall on Instagram
March Issue 2024 v Food & Beverage Magazine | Page 12

Carla’s Cornbread

Directions
Cornbread
1 c yellow cornmeal
1 tbsp sugar
2 tsp baking powder
¼ tsp salt
2 large eggs
½ c buttermilk
½ c canned cream-style corn
¼ cup 1 tbsp canola oil
Cinnamon Butter
4 oz 1 stick) salted butter, softened
½ tsp ground cinnamon
2 tsp powdered sugar
½ tsp almond or vanilla extract
Place four 3.5-inch cast-iron skillets* in the oven, then preheat it to 425ºF. Be very careful not to touch the hot skillets without oven mitts or potholders and be sure to have an adult help with taking the skillets in and out of the oven.
In a medium bowl, combine the cornmeal, sugar, baking powder, and salt. In a small bowl, whisk together the eggs, buttermilk, creamed corn, and ¼ cup oil.
Pour the wet ingredients into the dry ingredients and mix until smooth. Using oven mitts or potholders, take the hot skillets out of the oven. Divide the remaining 1 tablespoon oil between the skillets, quickly tilting the pans so that the oil coats the bottom and sides, and then pour the batter evenly into the skillets. The batter will begin sizzling right away.
Put the skillets in the oven and bake until golden brown and a cake tester inserted in the center comes out clean, about ten to thirteen minutes. Remove the hot skillets from the oven and place on a cooling rack to cool slightly.
While the cornbread bakes, prepare the cinnamon butter. In a medium bowl, mix all the ingredients with a rubber spatula. Stir until everything is mixed well and is an even color (no streaks). Transfer the butter into an airtight container.
Serve the cornbread hot or warm with a dollop of cinnamon butter. This recipe makes four 3.5-inch round cornbread.

Page 13 | Food & Beverage Magazine v March Issue 2024

Ingredients
Lemon Blueberry Bread with Lemon Glaze
Directions
Preheat your oven to 350°F. Grease and flour a 9 5 inch loaf pan.
1/2 cup unsalted butter, softened
1 cup granulated sugar
2 large eggs
2 teaspoons grated lemon zest
1/2 cup whole milk
2 cups all-purpose flour
2 teaspoons baking powder
1/2 teaspoon salt
1 1/2 cups fresh blueberries
For the Lemon Glaze:
1/2 cup powdered sugar
2 tablespoons fresh lemon juice
In a large mixing bowl, using a hand held mixer or stand-up mixer, cream together the softened butter and granulated sugar until light and fluffy. Add the eggs one at a time, beating well after each addition. Stir in the grated lemon zest and whole milk.
In a separate bowl, whisk together the flour, baking powder, and salt. Gradually add the dry ingredients to the wet ingredients, stirring until just combined.

Gently fold in the fresh blueberries, being careful not to crush them.
Pour the batter into the prepared loaf pan and bake for 60 70 minutes, or until a toothpick inserted into the center comes out clean.
While the bread is baking, prepare the lemon glaze by whisking together the powdered sugar and fresh lemon juice in a small bowl.
Once the bread is finished baking, remove it from the oven and let it cool in the pan for 10 minutes. Then, remove it from the pan and place it on a wire rack to cool completely.
Drizzle the lemon glaze over the cooled bread and serve.

March Issue 2024 v Food & Beverage Magazine | Page 14
PREP TIME 15 minutes COOK TIME 1 hour10 minutes ADDITIONAL TIME 10 minutes
Sweet Potato Beignet
Ingredients
4 cups all-purpose flour
⅓ cup sugar
1 packet rapid rise dry yeast 2¼ teaspoons)
1½ teaspoons table salt
1¼ cups whole milk
6 tablespoons unsalted butter, cut into 1-inch & room temperature
½ cup sweet potato puree, room temperature
1 large egg, beaten, room temperature
Vegetable oil, for the bowl
Vegetable oil, for frying
Powdered sugar, for dusting
Directions


In the bowl of a stand mixer, combine 2 cups of flour, sugar, yeast and salt. Set aside.
In a microwave safe bowl or 4-cup Pyrex cup combine the milk, butter and sweet potato puree for 30 45 seconds until warm (not hot! and the butter is not completely melted. Stir until butter is melted.
Pour the milk/butter mixture into the flour mixture and stir to combine. Add the egg. Place the bowl on the mixer fitted with the paddle attachment. On low speed, add 1 cup of the remaining flour. After incorporated, gradually add the last cup of flour. Mix until combined. Change to the dough hook attachment and knead on low speed for 10 minutes or until the dough is smooth and elastic.
Transfer the dough to a very lightly oiled metal bowl. Turn the dough to coat in the oil, then cover with plastic wrap. Let rise in a warm place until doubled in size, about 1 hour.
Once the dough has risen, roll it out into a long rectangle about 18 12 inches on a well floured surface.
Using a sharp knife, cut the roll into 24 equal portions. Cover loosely with a dish cloth and allow to rise for another hour until doubled in size and puffed up.
Heat the vegetable in a large sauce pot to 350℉. Fry the beignets until they are golden brown and no longer doughy. Remove from the oil onto a paper towel. Dust generously with the powdered sugar.
Page 15 | Food & Beverage Magazine v March Issue 2024

MUSIC MATTERS TO YOUR CUSTOMERS
NEW STUDY CONFIRMS MUSIC CAN INCREASE REVENUE AND BUILD CUSTOMER LOYALTY
89% OF MILLENNIALS SAID THAT GOOD MUSIC MAKES A MORE MEMORABLE EXPERIENCE
86% WOULD RETURN TO AN ESTABLISHMENT IF THEY LIKED THE FEATURED LIVE MUSIC
86% WOULD RECOMMEND THE ESTABLISHMENT IF THEY ENJOY THE MUSIC
80% SAY THAT MOST OF THE RESTAURANTS AND BARS THEY FREQUENT HAVE MUSIC PLAYING
FOR MORE INFORMATION ON HOW TO OBTAIN A BMI MUSIC LICENSE, PLEASE VISIT WWW.BMI.COM/EDE
NEARLY
70% OF MILLENNIALS SAID THAT HAVING NO MUSIC NEGATIVELY IMPACTS THEIR EXPERIENCE
IF GOOD MUSIC IS PLAYING
NEARLY 80% WILL STAY LONGER NEARLY 60% WILL BUY MORE FOOD OR DRINKS
70% MILLENNIALS
63% GEN X
56% GEN Z
BAR AND RESTAURANT OWNERS WEIGH IN
“
CHECK AVERAGE TENDS TO GO UP 5 TO 10% JUST BECAUSE PEOPLE ARE GETTING THAT 2ND OR 3RD DRINK. REVENUES HAVE JUMPED ALMOST 25% ON THE NIGHTS THAT WE HAVE LIVE MUSIC.
VIEW THE COMPLETE SURVEY, VISIT
“
WITH LIVE MUSIC (…) THERE WERE MORE LIQUOR SALES, AND THAT’S A 75% PROFIT MARGIN.
THE MORE UPBEAT, THE BETTER CHANCE FOR AN UPSELL, THE BETTER CHANCE THEY WANT TO STAY A LITTLE LONGER.
-CHRISTOPHER
VINEYARD OWNER AND TASTING ROOM OPERATOR LOS ANGELES, CA
”
https://www.bmi.com/pdfs/publications/2023/bmi-value-music--research-analysis.pdf
* A QUANTITATIVE ONLINE STUDY BY BMI AND NATIONAL RESEARCH GROUP (NRG) WAS ANSWERED BY 1,000 NATIONALLY REPRESENTATIVE PEOPLE AGE 21+ WHO REGULARLY VISIT EDES (AT LEAST 3X PER MONTH). TO REPRESENT THE B2B PERSPECTIVE, NRG CONDUCTED SIX IN-DEPTH-INTERVIEWS WITH OWNERS, OPERATORS AND MANAGERS OF BARS AND RESTAURANTS.
-BRIAN BREWERY OWNER, COLORADO AND UTAH
”
-THOMAS OWNER, FAMILY ITALIAN RESTAURANT ATLANTA, GA ”
“
TO
Driving Growth & Creative Development

Maya Dalla Valle
Winemaker, Dalla Valle Vineyards
Dalla Valle Vineyards is a family legacy that began in 1986 when Japaneseborn Naoko Dalla Valle moved from the West Indies to Napa Valley with her Italian husband Gustav Dalla Valle. Today, their daughter Maya is continuing her parent’s stewardship of the vineyard and dedication to creating exceptional terroir driven wines while also forging her own legacy as an industry leader. One of just a few second-generation female winemakers leading the Napa of Dalla Valle Vineyard’s rich history and her bold vision for the future.
Page 17 | Food & Beverage Magazine v March Issue 2024

Nadia Caterina Munno
Personality, The Pasta Queen
Nadia Caterina Munno, a New York Times and Wall Street Journal bestselling author and Italian icon, is celebrated for her contagious energy, love for people, classic recipes, and spreading the beauty of Italy worldwide. Born and raised in Rome, Italy, she comes from a long family line of pasta makers dating back to the 1800s. To millions of followers across her social channels, she is The Pasta Queen, sharing her mouthwatering and unique recipes in the kitchen with a healthy side of authenticity, wicked humor, and dramatic storytelling. Nadia has appeared on shows like TODAY, The Drew Barrymore Show, Sherri, and Good Morning America, and Entrepreneur Magazine has dubbed her “a force to be reckoned with in the digital space.
Philana Bouvier
President, Demeine Estates
Philana Bouvier is the President of Demeine Estates where she provides leadership and vision in creating a best-in-class sales and marketing organization. The fast-paced and evolving nature of the wine industry is wellsuited for Philana’s dynamic personality and work ethic, rooted in a quest diversity in the wine and spirits industry and was named to Wine Enthusiast’s Future 40 list in 2023 for inspiring innovation and helping to bring the drinks business into the future.


Meghan Zobeck
Winemaker, Burgess
Meghan’s career started in a very different world than wine, negotiating NFL player contracts for the Denver Broncos. Working extremely hard for several years, Meghan created a space for herself in this niche world, challenging the preconceived notions of who someone working in football should be. A lover of wine, Zobeck pivoted and started making her own in her Denver basement. She became an obsessive student of the science and alchemy of fermentation, falling deeply in love with wine. Leaving professional football and shifting her energy to wine, Meghan worked harvests in four countries, and sought out great winemakers to mentor and teach her. As the winemaker for Burgess (under the Lawrence Wine Estates portfolio), Meghan is revolutionizing this historic winery and is known as a leader in promiscuous farming.
March Issue 2024 v Food & Beverage Magazine | Page 18

Brittany Sherwood
Winemaker, Heitz Cellar
Brittany was fascinated with biology and living organisms—an interest that her passion for wine and shifting her major to Viticulture and Enology; she would go on to gain winemaking experience in Europe and Oregon. Under the Lawrence family’s leadership and as only the third winemaker at the iconic Heitz Cellar, Brittany remains excited to carry the iconic Heitz Cellar’s traditions forward. Brittany’s approach to winemaking is one of minimal intervention that highlights each vineyard’s unique qualities, as well as vintage expression. Brittany works closely with vineyard management, from poring over shoot thinning schedules in summer to choosing smaller picks between blocks at harvest. She oversees and manages the production and laboratory team to ensure quality every step of the way, from crush and fermentation to the wines’ extensive aging and determining when they are ready for bottling.
Joann Spiegel
Vice President, Miracle and Sippin’ Santa
Joann Spiegel has over 25 years of experience in the bar, restaurant, and hospitality industry. She has been recognized by her industry peers, media, and beverage brands alike, and dedicates herself completely to the art of great service. Joann has her hand on every part of Miracle’s successful growth and development as a business. She and her team are the direct line of contact for technical and logistical support for over 200 Miracle and Sippin’ Santa locations worldwide. Prior to joining the Cocktail Kingdom team as Director of Operations for their Logistics Division and now the Vice President of the Miracle and Sippin Santa brands, Joann was a bar manager and bartender at the award-winning cocktail bar, Dead Rabbit Grocery and Grog. Joann is also through her hands to be adapted into cocktails that universally work in so many markets around the world.

Page 19 | Food & Beverage Magazine v March Issue 2024



Changing the Way People Think About Whiskey

Von Payne Spirits LLC, a craft spirit company based in Clearwater, Florida, has crafted a truly unique product that has captured the eyes of connoisseurs and newcomers alike. The introduction of Von Payne Black, a Premium Blended Whiskey infused with Natural Black Currant, challenges the norms traditional whiskey market and invites everyone to “Discover the Pleasure of Payne.”
Former tech CEO and entrepreneur, Steve Allen, drew inspiration from four adult daughters and a lifetime of living on the fringe of alternative cultures. As a traditional bourbon drinker himself, he thought if “I could make a bourbon my daughters would drink, I could open up a new space in the market.” After years of experimentation and countless designs, Von Payne Black was brought to market in 2021.
The launch of Von Payne Black is not just another addition to the market; it’s a challenge to the status quo, in a sea of brown bottles, Von Payne Black stands out. With its distinctive packaging, including the iconic gargoyle pour spout, decanter style bottle, and It’s an invitation to bring people together for unforgettable experiences and conversations.
“Von Payne is different on purpose. We do not have a category. We do not fit in. You won’t understand us until you spend time with us, share us, and taste how uniquely special Von Payne is.”
Von Payne’s journey is not just about crafting exceptional whiskey; it’s about creating moments and fostering new connections. As Steve Allen puts it, “Von Payne is different you spend time with us, share us, and taste how uniquely special Von Payne is.”
mark, capturing the imagination of whiskey lovers, bourbon enthusiasts, and those drawn to alternative subcultures. Its unique blend of innovation and tradition offers a taste experience unlike any other, inviting you to Discover the Pleasure of Payne!
90 Proof Von Payne Black Blended Whiskey infused with Natural Black Currant is available for purchase in Florida, Texas, Ohio, Illinois, Michigan, Kansas, Louisiana, and online.
For more information about Von Payne Black and the Von Payne brand, visit their website VonPayne.com and follow them across all social media.
VonPayne.com / Facebook.com/VonPayneWhiskey Instagram.com/VonPayneWhiskey

March Issue 2024 v Food & Beverage Magazine | Page 22

Page 23 | Food & Beverage Magazine v March Issue 2024

March Issue 2024 v Food & Beverage Magazine | Page 24
SHINING A SPOTLIGHT ON THE LEADING LADIES IN THE INDUSTRY
Highlighting their achievements, contributions, and inspiring journeys
THE SPOTLIGHT

JANE HERNANDEZ
OF BODEGA TAQUERIA & TEQUILA
Born and raised in the sun-kissed city of Los Angeles, California, Jane Hernandez has more than two decades of creative expertise under her apron. With a prolific track record in culinary ideation, product/program development, and concept prototyping, Hernandez holds the distinguished title of Vice President of Culinary at Bodega Taqueria & Tequila, the rapidly expanding national brand renowned for its fast-casual taco joint-by-day and speakeasy-style lounge-bynight concepts. Throughout her career, Hernandez has held executive positions with globally-recognized companies such as Subway and Starbucks, as well as notable hospitality brands like Kimpton Hotels, PKR Group and Trio & Spectra Restaurant Group. In her new role with the South Florida-based brand, Hernandez oversees everything from scratch development of new menu items to the development of the culinary teams at Bodega’s multiple locations across South Florida, Chicago, and coming soon to Nashville and Washington D.C. A proud alumna of the California Culinary Academy in San Francisco, California, Hernandez spent her formative years in the kitchen of Farallon in the Bay Area.Having recently moved from Seattle to Miami, Hernandez is excited to create authentic and innovative culinary experiences at Bodega Taqueria y Tequila that reflect her impressive pedigree, California-inspired style, and her commitment to community and team camaraderie.
Page 25 | Food & Beverage Magazine v March Issue 2024

ADRIENNE GRENIER
OF BURLOCK COAST AT THE RITZ-CARLTON, FORT LAUDERDALE
Adrienne Grenier, culinary school graduate with a Bachelor’s in Food Science and Nutrition, began her career in 2005 at 3030 Ocean Restaurant, learning under esteemed chefs Dean Max and Paula DaSilva. She honed her skills in Southern California, cooking at Gordon Ramsey’s Michelin-starred restaurant before returning to South Florida in 2010 to work with DaSilva again at 1500 Degrees Restaurant, earning acclaim and winning Food Network’s Chopped. Returning to 3030 Ocean as Executive Chef, Grenier emphasized local produce and seafood before a stint in Brooklyn where she opened Pasta Louise amidst the pandemic. In 2023, she returned to South Florida as Chef de Cuisine of Burlock Coast, where she demonstrates her capacities as one of South Florida’s foremost culinary talents by incorporating her innate skill in combining flavors found in locally sourced ingredients into the modern coastal cuisine featured in the restaurant’s diverse menu.
PAULA DASILVA
OF THE RITZ-CARLTON, FORT LAUDERDALE
Director of Culinary and Beverage at The Ritz-Carlton, Fort Lauderdale Paula DaSilva is directly responsible for the property’s culinary outlets, beverage and wine program, in-room dining, Club Lounge, stewarding, purchasing and receiving and banquet operations. In addition, she continues to refine and strengthen operational and financial excellence with a substantial focus on elevating the customer experience. She brings more than two decades of expertise in professional cooking, kitchen management and an unyielding dedication for excellence to the property. Prior to this position, DaSilva served as Executive Chef, a role in which she executed innovative and speed-to-market offerings to position Burlock Coast amongst Fort Lauderdale’s top culinary destinations. DaSilva, who also worked at 3030 Ocean at the Harbor Beach Marriott in Fort Lauderdale under Chef Dean James Max, earned a slot on Season 5, in 2009, of FOX’s Hell’s Kitchen with Gordon Ramsey; she finished as the season’s runner-up and fan favorite, cementing her place as one of Florida’s celebrity chefs.

March Issue 2024 v Food & Beverage Magazine | Page 26

MARTA DE LA CRUZ MARRERO,
FOOD & BEVERAGE OPERATIONS MANAGER
THE RITZ-CARLTON, FORT LAUDERDALE
Marta De La Cruz Marrero stands as a dynamic and accomplished Food and Beverage Operations Manager at the prestigious The Ritz-Carlton, Fort Lauderdale. With over 19 years of rich experience in luxury and lifestyle hotels, resorts, and restaurants, Marta’s journey to management roles showcases her dedication and mastery of operations across the dynamic hospitality industry. Marta’s exceptional skills and decision-making prowess have led to numerous accolades, including the coveted SABRE Restaurateur award by Marriott International in 2018. Selected from 900 nominees, she emerged as a global discipline award winner, securing a place in the top 10 and winning the Americas, competing against the world’s best restaurateurs within the Marriott company. Marta was also named as the 2021 Leader of the Fourth Quarter, a prestigious honor awarded by The Ritz-Carlton Hotel Company, L.L.C. A foodie and cocktail aficionado at heart, Marta loves exploring different restaurants and bars, enjoying beach days, and taking her dog on car rides and park visits.
SAMANTHA KANTERMAN,
EXECUTIVE PASTRY CHEF
THE RITZ-CARLTON, FORT LAUDERDALE
Samantha Kanterman, the Executive Pastry Chef at The RitzCarlton, Fort Lauderdale, brings innate creativity and a passion for flavorful ingredients to the culinary world. Her professional journey, fueled by a Bachelor’s degree in Restaurant Management from the esteemed Rosen College of Hospitality Management at the University of Central Florida, is a testament to her dedication and love for the art of pastry making. Her inspiration to dive into the fast-paced hospitality industry stems from a profound appreciation for the community and connections fostered over meals. Samantha is particularly moved by the ability of food, especially desserts, to bring together individuals from diverse backgrounds, culminating in a shared, sweet ending. When she’s not orchestrating the dessert symphony at The Ritz Carlton, Fort Lauderdale, Samantha indulges in her hobbies, which include soaking up the sun at the beach, lifting weights, and immersing herself in music. Her favorite culinary creation? Oreo Cheesecake.

Page 27 | Food & Beverage Magazine v March Issue 2024

ROXANA GARCIA
Roxana Garcia, a culinary professional hailing from Venezuela, discovered her love for cooking through the fond memories of her mother’s kitchen. Inspired by her family’s culinary traditions, Roxana pursued a career in gastronomy, starting with roles in events and catering before making her mark in the culinary scene of the United States. Throughout her career, she has worked with renowned establishments like Bocas Group and Hilton, and even ventured into entrepreneurship with her own business, Kapas Food. Now serving as the Executive Chef at Fox’s Lounge in South Miami, a Lost Boy & Co. concept, Roxana continues to delight patrons with her creative flair and impeccable execution. Her approach to cuisine blends tradition with innovation, resulting in dishes that tell stories and bring people together.
MARTHA PALACIOS
JARANA
With a vibrant career spanning over two decades, Martha Palacios has seasoned her keen culinary skills across South America, stirring up flavors in Peru, Colombia, Argentina, and Chile. Her international exposure is vast, including a significant decade in Japan. Born in Lima, Peru, Martha’s culinary journey has been shaped by her education at San Ignacio de Loyola University and influenced by her grandmothers’ teachings from Cuzco and Lima. With significant roles at renowned establishments like Panchita and La Mar by Gastón Acurio, Martha’s leadership as Executive Chef at JARANA in Aventura highlights her commitment to authentic Peruvian cuisine and the philosophy of cooking with love. Beyond her culinary achievements, Martha’s dedication to her family and her joy in both the kitchen and personal life reflect her passion, earning her recognition such as the title of “Best Female Chef” by El Comercio in 2022.

March Issue 2024 v Food & Beverage Magazine | Page 28
OF FOX’S LOUNGE

SUMMER BAILEY
OF BOULON BRASSERIE
A graduate of Pastry Arts at the French Culinary Institute, Executive Pastry Chef, Summer Bailey, brings a resume adorned with all the great New York finesse that restaurateur Jeff Gigante was looking for when building the opening team for his Next Level Brands’ concept Boulon, a french Brasserie that opened January 2023 in the heart of Water Street. Bailey studied under Christina Tosi of Momofuku’s MilkBar, a dream-job at the time. She shares Tosi’s approach to dessert-making. “Desserts should make you feel like you are traveling back to a time in your childhood,” she says, “they should bring you a sense of time and place that ultimately conjures the sweetest memory.” During her years spent under celebrity chef Andrew Carmellini at The Dutch in New York she was recognized for those efforts, which quickly graduated her from pastry cook to pastry chef. The promotion came with recognition in- and out- of the kitchen, and followed her to Tampa where she got her Florida start as Executive Pastry Chef at the iconic Bern’s Steak House. Bailey has been recognized by media outlets like Vogue, Real Simple, First We Feast, Time Out NY, and Food & Wine Magazine for her delicious desserts, and says that even the hard-working have “pinchme moments.” Two of her career highlights include participating in Dominique Ansel’s Midnight in Paris during New York City Wine & Food Festival, and preparing her play on a Louisiana staple - a bananas foster souffle - for CNN’s “Just Desserts.” In her role as Executive Pastry Chef, Bailey oversees Boulon Bakery and all of the Next Level Brands’ dessert programs.
ASHLEY STANTON
OF ISABELLE’S GRILL ROOM & GARDEN, THE RITZ-CARLTON, COCONUT GROVE
A native of Buffalo, New York, Ashley Stanton has been part of The Ritz-Carlton family in Florida for a majority of her food and beverage career. A member of The Ritz-Carlton Coconut Grove, Miami culinary team since 2012, most recently in the role of Executive Sous Chef, Stanton now serves as Executive Chef for the entire property. Across all elements of culinary operations, she brings nearly 15 years of expertise, creativity and unyielding dedication to the resort. Upon joining the brand, she rose through the ranks across a variety of positions at the property, gaining extensive management experience and familiarizing herself with Coconut Grove and the market’s evolving tastes. Stanton has received a number of awards and recognition for her culinary management skills, has competed in television competitions such as Guy’s Grocery Games on Food Network, and keeps her playful side in the spotlight with creations such as her Smithworks Vodka first place award-winning Buffalo Chicken Wing Bloody Mary. Her intimate knowledge of the brand and clientele, coupled with her passionate energy for hospitality, led her to be named Executive Chef of the property in 2021.

Page 29 | Food & Beverage Magazine v March Issue 2024

LAURA BACKSMAN
OF FORBICI MODERN ITALIAN
HEATHER RIVAS
OF BOULON BRASSERIE
As an industry veteran with over 15 years of experience in high volume, casual, and fine dining restaurants, Heather Rivas brings a wealth of knowledge and passion to her position as General Manager of Next Level Brands’ brand-new Boulon Brasserie in Tampa, Florida. An Ohio native who studied Health & Nutrition at the University of Cincinnati, Rivas has dedicated her career to learning and understanding people, food, and the relationship between the two. With an unquenchable appetite for knowledge of the hospitality industry, combined with her ambitious nature, Rivas honed her restaurant business acumen at some of the top destinations on the East Coast and in the Lowcountry, including New York City, Boston, Providence, and Savannah. Over the course of her career, she has had the opportunity to work at many prestigious restaurants, most notably as General Manager for James Beard Award-winning chef, Sean Brock at his acclaimed restaurant Husk Savannah and as opening General Manager at Tiger Mama, a Boston restaurant helmed by James Beard Award-nominated chef Tiffani Faison. Rivas also spent the early part of her career as the General Manager at Mill’s Tavern, the Forbes Four-Star restaurant in Providence, Rhode Island. Her connection to food, wine, and service, along with her experience opening restaurants, has given her the opportunity to work in different markets and she now brings her talents to Tampa. With a healthy dose of wanderlust and a keen interest in international communities, Rivas has traveled the world, which contributes to her overall appreciation for culture, food, and storytelling. She is devoted to her craft, particularly wine, and boasts two Wine Spectator Awards of Excellence for lists she has curated. She was also invited to the James Beard House and had the honor to pair wines for a Regional Spotlight dinner, in which she was acknowledged for her outstanding contribution. Additionally, Rivas holds a Court of Masters Sommeliers Level 1 Certification and plans to continue her advancement within the Court.
An industry veteran with over 15 years of experience in restaurant management, Laura Backsman brings a wealth of knowledge and skills to her General Manager position at Forbici Modern Italian in Tampa, Florida. Backsman’s venture into restaurant management came at just 19-years-old. While her peers were sleeping in, she was opening a bakery at 4:30 a.m. She says, “I was bitten by the hospitality bug, and never looked back.”Her commitment to creating memorable experiences for guests has been a skillset that she has honed throughout her career. For Backsman, joy is making others happy – turning ordinary moments into memories and making regulars feel like family. Backsman credits much of her industry know-how to Next Level Brands partner and hospitality powerhouse Jeff Gigante, who mentored her into her current position as General Manager. Backsman adheres to famed restaurateur Cameron Mitchell’s slogan, “Yes is the answer—What is the question?” and says prioritizing others’ feelings is key, whether it’s the guests or the teams. When Backsman is not in the restaurant, you can find her creating unique oil paintings. If you’ve ever admired Forbici’s amazing chalkboards, you’ve admired her work.

March Issue 2024 v Food & Beverage Magazine | Page 30

MICHELLE BERNSTEIN
Born and raised in Miami of Jewish and Latinx descent, Chef Michelle “Michy” Bernstein is a fixture in the culinary world, paving the way for bright Latin flavors and standout ingredients in her lively, vibrant cuisine. These days, Bernstein’s schedule is more jam-packed than ever, juggling multiple projects with her husband and business partner, David Martinez, while hosting several cooking shows on television. Together, they own and operate Michelle Bernstein Catering, developing incredible menus for catered events large and small. In 2019, Bernstein and Martinez teamed up to open the awardwinning Café La Trova on Calle Ocho in the heart of Miami’s Little Havana neighborhood. Additionally, they are partners in the internationally recognized Miami Beach cocktail bar, Sweet Liberty, as well as La Cañita located in Miami’s Bayside Marketplace which celebrates the food and flavors of the Caribbean with influences from Central and South America. More recent projects include Michy’s Chicken Shack and Lunchería, both located in the new Downtown Miami food hall, Julia & Henry’s. Coming soon, a modern take on the beloved, award-winning Sra. Martinez will open in Coral Gables (2023). Sra. Martinez promises to bring an experiential and exciting dining, cocktail and live music venue to the area. Bernstein also devotes time to causes she is passionate about, including Common Threads, a national program that she brought to the South Florida community to teach underprivileged children about cooking and eating healthy.
HANNAH THOMAS
OF BERN’S STEAK HOUSE
A graduate of Le Cordon Bleu, Executive Pastry Chef Hannah Thomas’ tenure at iconic Bern’s Steak House and Harry Waugh Dessert Room, has covered some of the restaurant’s most challenging times, including the pandemic when the industry was rattled. Chad Johnson, the team’s Executive Chef, notes that “Hannah has an ability to lead by example, stay calm under pressure, and seek guidance to grow in her role at Bern’s.” Thomas credits her earlier learning from working with Chef Pat at Streamsong Resort where she learned to make desserts that were pieces of art. After several years with the resort, Hannah accepted the position at Bern’s, where there’s not only a dessert selection, there’s an entire dessert room, upstairs above the dining rooms. Visitors from around the world indulge in delectables offered at the Harry Waugh Dessert Room.

Page 31 | Food & Beverage Magazine v March Issue 2024











When there is a new universe of possibilities




THE CACAO POWDERS















Extra Brute Plein Arôme Nature Cacao Légère 1% Noir Intense
COLLECTION
settle
UNIVERSELLE NATURELLE PERFORMANTE Explore the cacao powders www.cacao-barry.com @cacaobarryofficial
Why
for ONE?

Esteemed Cognac Cellar Master and Creator of Grey Goose Vodka
Cardinal du Four
that François Thibault, the renowned distiller/master blender of Cognac and creator of Grey Goose Vodka recipe, is joining the Cardinal du Four Armagnac
time friends, often reunite and, as always, bond over their shared French epicurean passions, delving into discussions on gastronomy, wines, and spirits.
Driven by the same passion and product excellence, they took on the challenge of creating together an exceptional new Armagnac blend. An opportunity for
spirit from the French region of Armagnac where the
terroirs and traditions have for centuries expressed a style that is as unique as it is rare.
With his exceptional reputation in the spirits industry, François Thibault brings his unparalleled expertise and passion to the world of Armagnac. As he embarks on this new chapter in his illustrious career, he continues to raise the bar for the spirits industry. Through his unfaltering dedication and profound understanding of his craft, he sets a new standard of excellence, ensuring that future generations will continue to appreciate the remarkable spirits he creates.
testament to François’ meticulous craftsmanship, he will play a pivotal role in shaping the future of
Page 33 | Food & Beverage Magazine v March Issue 2024
our brand, while infusing his signature touch and innovative to groundbreaking innovation will surely elevate our company to new heights.”
“In a relatively short time, Christophe has made his mark in the industry, introducing Cardinal du Four Armagnac to the North American luxury spirits market,” adds Thibault. “I’m pleased to join him in the evolution of the brand, and look forward to sharing my expertise with both connoisseurs and those who newly discovered the distinct charm and appeal of Armagnac.”
CdF stands out in the market, offering a truly extraordinary experience for discerning spirits connoisseurs. With Thibault’s expertise, each bottle of CdF Armagnac, considered the oldest brandy in France, will showcase the culmination of
With an illustrious career spanning over four decades, François Thibault has not only established himself as a pioneer in the spirit industry but has also numerous accolades, including the which acknowledges his unrivaled mastery in the art of spirits crafting.
Thibault recently received
exercise of their profession. Furthermore, he received the medal of “Knight of Agricultural Merit” for his commitment and services rendered in the world of agriculture.
Born and raised in France, his deep appreciation for spirits was fostered through his family roots in the Cognac region.
to pursue a formal education in viticulture and oenology,
“The success of Cardinal du Four, 21 Rébellion is a testament to François’ meticulous craftsmanship, and we’re delighted that he has offcially joined the CdF family,” comments Namer.


ELEVATE FOODSERVICE QUALITY WITH
In the dynamic world of foodservice, where every detail matters, Novipax stands as a beacon of innovation and reliability. Novipax’s mission is to combat unwanted moisture and liquid through quality products, and a profound dedication to creating a safer world.

Page 35 | Food & Beverage Magazine v March Issue 2024
TM
DEFINING NOVIPAX: A LEGACY OF INNOVATION
At the core of Novipax is a legacy built on excellence. Our brand is not just about products; it’s a commitment to elevating the foodservice industry as a whole. Novipax thrives on the belief that fresher ingredients and improved food quality can enhance every dining experience.
e ha e a long history of man fact ring reliable, high performance absorbent pad sol tions for the food and heathcare mar ets. o ipa is the name that is tr sted. said Keith Schroeder, CEO of Novipax. “As we look to expand our foodservice offering, we bring tenured experience, along with our key values embedded in reducing food waste and striving to implement innovative products where they may not be used today.”
From front-of-house to back-of-house, Novipax helps restaurants serve the tastiest food in the safest conditions. No matter what’s on the menu, foodservice customers want the same thing: the freshest food prepared in the cleanest environment. Novipax’s solutions enhance food freshness, promote kitchen hygiene, and support employee and restaurant patron safety for restaurants of every size and style, from fast food chains to fine dining establishments.

 said Keith Schroeder, CEO of Novipax.
said Keith Schroeder, CEO of Novipax.
March Issue 2024 v Food & Beverage Magazine | Page 36
FOODSERVICE PORTFOLIO: MORE THAN JUST SUPPLIES
PREP PADS: YOUR KITCHEN SIDEKICK
Prep Pads are the moisture management solution you need to maintain maintain optimal texture and freshness. Furthermore, by incorporating the pads into the prep process you will the freshness and improved quality delivered by Novipax’s Prep Pads.


SPILLGUARD: NAVIGATING THE KITCHEN CHAOS
it’s a testament to Novipax’s dedication to creating safer work environments. Engineered with advanced technology, Spillguard swiftly tackles spills, preventing slips and mishaps, fostering a kitchen atmosphere where safety reigns supreme.
VERSAMAT: GUARDIANS OF CLEANLINESS
of cleanliness and safety. With a focus on easy maintenance and durability, this product proactively absorbs unwanted moisture that even becomes a problem.

With Prep Pads and other Novipax innovations like SpillGuard products to help you solve any unwanted moisture issues that you are facing in your current operations.
A safer kitchen and less unwanted moisture means chefs can focus on what they do best – crafting culinary delights!
True to our mission, Novipax has introduced an innovation we call “Prep Pads”. Prep Pads are the moisture management solution you need to maintain peak freshness in every dish, every time.
Page 37 | Food & Beverage Magazine v March Issue 2024

F&B HOLIDAY HIGHLIGHT
NATIONAL ESPRESSO MARTINI DAY!

Featured Cocktail Recipe: www.el-cristiano.com and follow @elcristianotequila
Espresso Martini XR
• 2 oz El Cristiano XR Extra Reposado
• 1 oz Espresso (freshly brewed from espresso machine or cold brew concentrate)
• ½ oz Simple Syrup
• ½ oz Coffee Liqueur (Kahlua)

• Shake Vigorously with ice
• Served in a Borough Martini Glass
• Coffee Bean garnish

In Celebration of the special holiday, please see the El Cristiano XR Espresso Martini featured. While espresso martinis became popular with vodka, the shift to tequila in the last year has been ever present. El Cristiano, proud to call themselves the world’s most delicious tequila, is additivefree, sustainable and therefore without hangover, was one of the first brands to promote their varieties with espresso martini, featuring recipes with both their Extra Reposado (XR) and their Extra Anejo (Black Label). In just under two years since launch, they have also already won over 32 awards and accolades, including the Pro%f 2023 Century Award.
Served at venues such as Wynn Hotels, Soho House, Waldorf Astoria, Margot, Juliet, Wally’s, Javier’s, The Hideaway and Cold Shoulder, their Espresso Martini XR has been a featured drink at Nobu Malibu as well, to much demand. El Cristiano can be picked up at Total Wines & More nationwide as well as liquor and convenience stores across California, Colorado, Nevada, Florida, Georgia, and New York, plus many more states that are added monthly. They are available via online liquor delivery apps in almost every state as well. The XR bottle retails for $110 to note, and their classic reposado at $65, silver at $45 and Extra Anejo for $135.

Page 39 | Food & Beverage Magazine v March Issue 2024
Pictured is the Espresso Martini featuring El Cristiano XR at Nobu Malibu
Pictured is the XR Extra Reposado El Cristiano Bottle


FLORIDA

MERCEDES CHAVEZ
Front of House Manager at Uchi Miami
Mercedes Chavez is the front of house manager at Uchi Miami by Hai Hospitality in Miami, Florida. Miami-born and -raised, Chavez grew up in a family with a passion for the hospitality industry. She attended Florida International University in 2010 as a pre-med student, but it was during her college years that she realized she couldn’t divert away from her love of restaurants. While still a student, Chavez began her humble adventure into the restaurant industry where she first landed a position as a cocktail server for Renaissance Hotels. She later made her way to Miami’s Pubbelly Sushi, where she began as a server before earning a swift promotion to the floor manager. Chavez later explored careers at Nikki Beach Miami, ZUMA Restaurants and Rhubarb Hospitality Collections, as well as worked as managers at El Bajareque Restaurant and The Drexel. In 2023, Chavez joined Uchi Miami as the trusted front of house manager overseeing the entire front of house operations. Though newer to the team, she’s in for the long haul. When asked what her future goals are, she said, “In three years, to become a general manager at Hai Hospitality. In five years, to be a part of Hai’s HR East Coast expansion. In ten years, to continue to invest in my career and help as many people as possible to evolve.”
Page 41 | Food & Beverage Magazine v March Issue 2024

FLORIDA FLORIDA

KAYTLIN DANGARAN
Executive
Chef at
Bistro at Sarasota Art Museum
Kaytlin Dangaran is the executive chef at Bistro at the Sarasota Art Museum of Ringling College and is the driving force behind the restaurant’s seasonal farm-to-table dining approach. She elevates the museum experience with art-inspired menus and draws inspiration from her diverse culinary experience and background. The French Culinary Institute-trained chef has multi-coast experience from renowned restaurants in New York, San Francisco, Miami and, now, Sarasota. During her years in between coasts, the Tampa native explored seasonal cooking, gaining expertise in a restrained style of creating dishes dictated solely by the ingredients’ seasonal availability. She’s participated in many national culinary events and cooked at the James Beard House for Taste America, representing Constellation Culinary Group. When she’s not in the kitchen, this dynamic chef is also a mother of two.

ELGIN WOODMAN
Executive Chef at Constellation Culinary Group
Elgin Woodman is the executive chef at Constellation Culinary Group in Miami, Florida. Growing up in Lima, Peru, she learned recipes, techniques and flavor profiles she still uses when creating large-scale event menus in South Florida. Of course, the years of study at both Florida International University and Johnson and Wales University increased her passion for culinary as well as molded her into the catering expert she is now. Woodman has been in the catering business for over 25 years, cooking for the most prominent and exclusive clientele of Miami, including celebrities and large corporations, in addition to collaborating with renowned chefs from around the world. She joined the Constellation team in 2021 as the Executive Chef, responsible for creating, developing and executing trend-setting menus for the catering division. One of her most impressive skills is her ability to mass produce a menu item and maintain a high level of quality from the first plate to the last. After years in the catering industry, Chef knows who makes the decisions at an event. When asked for advice for younger chefs, she said, “As a catering chef, sometimes you have to put your own taste and ideas aside to fulfill the client’s vision. At the end of the event, it’s satisfying to know that you made someone’s event very special.”
March Issue 2024 v Food & Beverage Magazine | Page 42

SHARLA EVANS
Director of Catering at Adrienne Arsht Center and SGWS Wynwood
Sharla Evans is the director of catering for Constellation Culinary Group at the Adrienne Arsht Center and SGWS Wynwood. Born in Saint Lucia, Sharla and her family moved to New York City where she grew up as the youngest of four children, including a twin brother. She graduated from the prestigious Culinary Institute of America in Hyde Park, NY in 2009 and finally settled in Miami with her high school sweetheart. Currently serving as the general manager and catering director at Constellation Culinary Group’s SGWS Wynwood, nestled at the vibrant heart of Miami’s arts and culture district, Sharla Evans oversees all facets of venue operations and catering services. In her role, she spearheads multiple chef-centric events, crafting programming, popup experiences and hospitality-driven engagements for SOBEWFF (South Beach Wine & Food Festival). At the Adrienne Arsht Center, Sharla orchestrates memorable events ranging from captivating pre- and post-show dinners to elegant weddings. Outside of her professional endeavors, Sharla is a devoted mother of two!

LILLIAN ROJAS
Director of Catering at Constellation Culinary Group
Lillian Rojas is the regional sales director at Constellation Culinary Group in Miami, Florida. A graduate of Florida International University, Rojas has over 25 years of experience in the hospitality industry, specializing in catering and events management. She joined Constellation in 2016 as the director of catering after her demonstrated history in the industry, including having worked as director of catering at Shelborne Wyndham Grand, director of catering and special events at Morimoto Restaurant, director of catering and conference services at Morgans Hotel Group, and more. In her role at Constellation, Rojas spearheads weddings, special events and celebrity soirees at the Perez Art Museum Miami and other Constellation venues including the Phillip and Patricia Frost Museum of Science, the Adrienne Arsht Center, SGWS Wynwood and more. Rojas attributes her success to the great relationships Constellation builds with local farms to ensure every event is catered with fresh and seasonal ingredients while staying on top of buzzworthy trends.
Page 43 | Food & Beverage Magazine v March Issue 2024
FLORIDA FLORIDA

NICOLE RESNICK
General Manager at Adrienne Arsht Center
Nicole Resnick is the general manager for Constellation Culinary Group at the Adrienne Arsht Center. Resnick holds a bachelor’s degree in International Relations and Affairs from Florida International University and an associate degree in Sociology and Anthropology from Kansai Gaidai University in Osaka, Japan—where she achieved near-fluency in writing and speaking Japanese. A self-described “jack of all trades,” Resnick has not only worked her way through the ranks with Constellation, but she has also held positions with other firms in human resources, bookkeeping and accounting — even as a personal assistant in the construction industry. In her current role, Resnick brings high energy and palpable passion to her position as general manager of Teatro and the Adrienne Arsht Center’s on-site bar and food/ catering programs.

TONI ROBERTS
Pastry Chef - The Ritz-Carlton Chicago
Chef Toni is one of Chicago’s most sought-after pastry chefs wielding the kitchen torch and other pastry tools at The Ritz-Carlton, Chicago, the luxury hotel nestled in Chicago’s Magnificent Mile. Past experience includes interning with acclaimed pastry chef Emily Luchetti at Farallon in San Francisco during her time at Culinary Institute of America. In 2009, Roberts had the privilege of assisting Marcus Samuelsson at the White House during his guest chef preparation of the Obama Administration’s first State Dinner. Toni‘s accolades include the Jean Banchet Award for Culinary Excellence for “Rising Star Pastry Chef” and winner of Pastryscoop.com’s “Best Dessert Menu ‘’ award. Time Out Chicago also selected her dessert as one of the “100 Best We Ate This Year.” Her passion for chocolate, superior skills and precision, and a good whisk is what brought her to be named executive pastry chef at The Ritz-Carlton, Chicago. Her decadent creations have become tasteful touches throughout the property: from Italian-inspired desserts at Torali to breakfast pastries and confections at The Café to showpieces adorning the hotel’s lobby during the holiday season. Roberts inaugurated the hotel’s in-house wedding cake program in 2023 creating over 50 glamorous cakes to date. In Chicago, she continues to participate as guest chocolatier for the AIDS Foundation Chicago (AFC)’s annual fundraising event World of Chocolate.
March Issue 2024 v Food & Beverage Magazine | Page 44
CHICAGO FLORIDA
Precision Fermentation Provides Nutrition Without Compromise
ADVANCES IN FERMENTATION TECHNOLOGY OFFER NEW APPROACHES TO IMPROVE FLAVOR AND TEXTURE, WHILE IMPROVING OVERALL NUTRITION.
By Ryan Slattery

There is a science to food. A challenging, yet delicate, balance of ingredients and methods to developing foods that are will have consumers coming back for more. That’s where Sarah Corwin, Ph.D, LDN, a Senior Principal Food Scientist
more nutritious for people.
What Corwin does–as an expert in carbohydrate chemistry, vegan mimetics, and nutrition–is to research and develop products by testing and monitoring how ingredients interact with each other to improve the quality of foods.
create ingredients to improve a variety of foods is through a process called precision fermentation. “What we’re looking to accomplish with precision fermentation is to develop ingredients that are produced in a sustainable way that can says. “It’s a very targeted way to produce ingredients. It can be more cost effective and oftentimes the ingredients are more functional as well.”
Sarah
Corwin, Ph.D, LDN, a Senior Principal Food Scientist at Ajinomoto Health & Nutrition (AHN)

Similar to how bread and beer are made using fermentation where the yeast feeds on sugars and starches to produce studying how microorganisms interact with certain agents to fermentation. MSG is the purest form of umami and delivers discovery and the development of MSG by Ajinomoto over 110 years ago, MSG has been used safely as a food ingredient through advanced precision fermentation technology, using quality ingredients such as locally grown Iowa corn. During this process, glucose is fermented and the result is MSG and water is evaporated through a drying process leaving only a while decreasing the need for salt. “That’s our goal,” says Corwin, “to produce ingredients that improve nutrition.”
OFTEN PLANT-BASED PRODUCTS, AS WELL AS SNACKS, ARE VERY HIGH IN SODIUM. SO, SCIENTISTS ARE LOOKING AT HOW TO IMPROVE NUTRITIONAL VALUE WHILE STILL MAINTAINING THE SAME FLAVORS
Fermentation technologies can be used to produce new ingredients that enable food scientists and product developers to create delicious foods that don’t compromise on taste, texture or nutrition. And food scientists are using foods.
March Issue 2024 v Food & Beverage Magazine | Page 46
Credit ©Adobe Stock by aperturesound
“IT DOESN’T TASTE LIKE IT’S MISSING ANYTHING BUT IT’S MORE NUTRITIOUS,” CORWIN SAYS. “THAT’S OUR GOAL.”
industry predicted they would. A recent study conducted by second biggest concern was nutrition.
“The goal [of the study] was to understand what it was that these individuals wanted,” Corwin explains. “We found taste and texture were the top issues for the Gen Z and Millennial texture actually scored higher as a priority for consumers than taste.”
Corwin says scientists can create a variety of textures to
ingredient list if it improved the product.
high in sodium. So, scientists are looking at how to improve of times that’s accomplished by reducing sodium and amping
“Umami is an essential component to developing food meat,” Corwin says. Umami elevates, enriches and improves meatiness, while kokumi is a taste sensation that brings depth and richness, and improves mouth feel. Paired together well, the food will taste better.
Using cheese popcorn as an example, Corwin says cheese powders often contribute a large quantity of the sodium
new protein binding systems can replace methylcellulose and
well as red meats like lamb, all while boosting protein content. Despite assumptions from marketers and retailers that study also overwhelmingly showed that most consumers don’t mind a longer ingredient statement if it improves the
creating a more nutritious product by adding a combination of umami and kokumi solutions to help reduce the overall amount of cheese powder needed.
“It doesn’t taste like it’s missing anything but it’s more nutritious,” Corwin says. “That’s our goal.”


HOLIDAY FLAVOR HIGHLIGHT
BEATBOX GREEN APPLE IS THE PERFECT SPLASH OF FLAVOR FOR ST. PATRICK’S DAY!
Green Apple offers the crisp, refreshing taste of green apples infused into every sip of the party drink ,in the form of a nostalgic party punch. BeatBox Green Apple brings a burst of vibrant flavor that perfectly complements the festive atmosphere of St. Patty’s Day, on March 17th. It is also reduced in sugar, gluten-free, recyclable, and resealable, which allow you to take the party with you.
Here’s why BeatBox Green Apple is the ultimate choice for any celebration: Below are the pillars they outline for the new Green Apple Party Punch flavor!
BOLD FLAVOR: Get ready to tantalize your taste buds with the bold and irresistible taste of fresh green apples.


CONVENIENCE: hours preparing complicated cocktails. Simply chill, pour, and enjoy! It’s the hassle-free solution to elevating your Saint Patrick’s Day festivities.
PARTY STARTER: Be the life of the party and impress your guests with this exciting and innovative beverage choice. BeatBox Green Apple sets the stage for a memorable celebration filled with laughter, good times, and great drinks.
We invite your readers to elevate their party experience and toast to the luck of the Irish with this deliciously bold flavor. With BeatBox Green Apple, it is not just buying a drink – but the perfect flavor combination to celebrate the Irish holiday tradition.

Here’s the scoop on where to snag BeatBox Green Apple: BeatBox is carried at convenient stores, liquor stores and retail stores nationwide, such as BevMo, Total Wine & More, 7 Eleven, The Liquor Bros and Walmart, plus delivery apps such as Drizly, DoorDash, Uber Eats. Green Apple is available as 500 ml /16.89 fl oz single tetras for $3.99.
Ecomm Website: https://beatboxbeverages.com/ Product: https://beatboxbeverages.com/products/green-apple

HERE’S TO AN EPIC ST. PATTY’S DAY BASH!






March Issue 2024 v Food & Beverage Magazine | Page 50 For more information contact: Amanda Tomsik Director of Foodservice & Adult Beverage atomsik@ECRM.MarketGate.com or call 440-528-0474 PUT YOUR FRESH FLAVORS & NEW MIXES ON THE MENU CONNECT WITH POTENTIAL PARTNERS IN PRE-SCHEDULED, ONE-ON-ONE MEETINGS. 2024 Foodservice and Adult Beverage Sessions • Foodservice • On & Of Premise Adult Beverage • Commercial Foodservice 30 YEARS OF EXCELLENCE: MAKING CONNECTIONS THAT MATTER



Expands Safe-T-Chef® Line With Anti-Fog Technology

The launch of Safe-T-Chef® brought this technology to hot food applications, making it the frst tamper evident, tamper resistant polypropylene product line available in the market
 By Ryan Slattery
By Ryan Slattery
For more than a half century, Inline Plastics has been the leading manufacturer of high quality, crystal clear, food packages for the restaurant industry, so it’s not surprising that the company is at the forefront of innovation once again.
Inline transformed the marketplace with the launch of their patented Safe-T-Fresh® tamper protection technology that gives consumers confidence the food contents within the package are secure and have not been tampered with. The launch of Safe-T-Chef® brought this technology to hot food applications, making it the first tamper evident, tamper resistant polypropylene product line available in the market. Not only has the line expanded in recent months, but all the vented options now include anti-fog.
“As third-party food delivery continues to grow, packaging is becoming an important component to retail and restaurant offerings,” explains Carrie Cline, Inline’s Senior Brand Manager. “Meals need to be able to travel safely. That requires keeping the contents protected and fresh while being passed from kitchen,

to shelf, to driver, to consumer. The more touchpoints, the greater the risk. Inline Plastics’ patented tamper protection technology minimizes that risk. This gives the consumer confidence that once sealed in the kitchen, the food inside the package has not been tampered with as it changes multiple hands during transportation. They have the visible assurance that the food inside is safe and secure.”
Safe-T-Chef® adds a level of security not seen in the industry and their vented options allow steam to dissipate in applications where food is packed hot or kept warm with heat lamps and hot displays. This keeps the food from getting soggy while in the packaging. All the vented options have the anti-fog feature to ensure the highest clarity possible, allowing the consumers to see the contents.
“Venting alone is not enough to release built-up heat inside a package,” says Cline. “This excess heat creates water vapor that condenses and forms droplets, fogging the inside of the package, obscuring the view of the food. Now, Inline has developed an anti-fog feature on the vented Safe-T-Chef® packages. The benefits of the anti-fog include improved visibility, appeal of the food and reduces food waste.”
Inline has had decades of experience with venting in their Safe-T-Fresh® product line made of PET. Venting allows air to flow for various reasons to keep the contents at peak freshness, this is especially important for dishes that contain vegetables that have high outgassing properties.

Inline has had decades of experience with venting in their Safe-T-Fresh® product line made of PET. Venting allows air to fow for various reasons to keep the contents at peak freshness, this is especially important for dishes that contain vegetables that have high outgassing properties.

As innovators in their market, Inline Plastics is staying ahead of the curve with their sustainability initiatives. In 2020, Inline launched their ‘reborn’ initiative becoming the first and only thermoformer of rigid plastic packaging to offer 10% post-consumer in all their PET product offerings. While many sustainability claims in the market are often unsubstantiated with companies making misleading “greenwashing” claims or using language like “sustainable,” “recyclable,” and “compostable” that confuse consumers, Inline has substantiated its claim through an independent third-party.
SCS Global Services, a worldwide leader in sustainability standards, has conducted an independent audit certifying that Inline products are ‘Made with 10% post-consumer recycled PET’.
“Integrity and transparency are an important part of the way Inline Plastics goes about business,” says Cline. “There are very few companies in the industry who share the data necessary to acquire a third-party independent certification.”
For more information on their vast line of award-winning products, visit InlinePlastics.com.
March Issue 2024 v Food & Beverage Magazine | Page 54






 By Kersten Rettig
By Kersten Rettig
In the fast-paced and dynamic world of the culinary arts, women have been carving out their space, making significant strides, and breaking barriers. At the forefront of empowering and
A Glimpse into Les Dames d’Escoffier International
Founded in 1976 by a group of remarkable women leaders in committed to advancing the achievements of women in the education, and promote philanthropy among women in the culinary profession and support communities through grants, scholarships, and mentorship initiatives.
Empowering Through Education:
to education and mentoring. Through programs such as The actively invests in women who are pursuing education as well as professional women who want to level up in their careers.
women have the resources they need to excel in their chosen fields.
These educational initiatives not only empower individuals but also contribute to raising the overall standard of excellence in the culinary industry. Through investments in women’s education, we cultivate a community of proficient and knowledgeable professionals who bring a varied range of perspectives and talents to the table.
Page 57 | Food & Beverage Magazine v March Issue 2024

Building Networks and Breaking Barriers:


industry connect, collaborate, and lift each other up. The organization understands the importance of breaking down barriers and creating a supportive community where women can share experiences, insights, and opportunities. This is particularly crucial, considering that each woman faces her unique challenges in the culinary industry, which persist as it remains predominantly male-dominated.
a platform for networking and mentorship, facilitating the exchange of ideas and fostering relationships that extend beyond professional boundaries. This network not only opens doors for career advancement but also creates a sense of solidarity and belonging.
Cultivating Philanthropy for a Greater Cause:
success. The organization actively engages in philanthropic endeavors and, since its founding, has raised and donated more than $10 million to support initiatives including hunger relief,

VICE PRESIDENT KERSTEN

education, food justice, and sustainability. By participating in these projects, women in the culinary industry affiliated with communities. This commitment to philanthropy enriches the lives of those in need and reinforces the values of compassion and social responsibility within the culinary community. Members are not just leaders in their field; they are also agents of positive change, using their skills and influence to address critical issues and contribute to a better, more sustainable world.
A Legacy of Excellence:
honoring the accomplishments of women in gastronomy. The organization’s legacy stands as an inspiration for present and upcoming generations, highlighting the remarkable influence excellence has significantly influenced the industry landscape, creating opportunities for women to excel in diverse culinary disciplines. As the organization flourishes, so does women’s collective strength and influence in the culinary world.
March Issue 2024 v Food & Beverage Magazine | Page 58
North Texas who has owned, worked in, and marketed restaurants.
trustee for the VNA Texas Foundation, a nonprofit provider of community-based healthcare including hospice care and Meals on Wheels delivery for whom she hosts a podcast series, “Aging Well with VNA.” She serves on the board of Chef to the Shelters, a non-profit that provides healthy meals to detox shelters and sober living homes in North
3RD
RETTIG




100 Mares
Made with organic fresh fruit, this agave spirit is all you need to taste the authentic flavors of Mexico. Stated as the new generation of the Tequila aisle, this top-selling agave spirit introduces a refreshing, high-quality drink ready to enjoy on the rocks. 100 Mares Mango flavor profile includes the sweetness and spice of the mango and the punch of the 100% blue Weber found in the valleys of Tequila. Its super smooth texture comes from macerating the mangos in the spirit until they achieve the perfect blend. If you are looking for a delicious ready-to-serve drink, you definitely have to try this Mexican delicatessen.

Anteel Tequila
Anteel Tequila is a premium sipping tequila brand that has won over 100 awards and accolades since 2019. Nayana Ferguson, cofounder, is the first black woman to have ownership of and lead a tequila brand. Nayana is an 18-year pancreatic cancer survivor and an 11-year breast cancer survivor. She is pre-diabetic and since tequila is naturally low in sugar, she became an enthusiast years ago before creating Anteel Tequila. Anteel is short for Antillean Crested Hummingbird and each bottle is adorned by a hummingbird logo in colors that represent the bright colors found on these beautiful birds. Anteel Tequila has five expressions in its portfolio and features the world’s only Coconut Lime Blanco and Tarocco Blood Orange Blanco. Both are infused with all-natural flavors and do not contain any sugars or sweeteners. The latest release is Anteel Anejo which is
Amazontella
It’s easy to bring the benefits of the Amazon rainforest directly to your table with the new, organic superfruits spreads from Amazontella. Choose from Cupuacu Fruit Spread, Acai Fruit
Spread, all 100% made from fruit. benefits of antioxidant-rich superfruits only found in the Amazon… easily spread on toast, cheese, fruit, or eaten directly from the jar.

March Issue 2024 v Food & Beverage Magazine | Page 60
Editor’s Top Pick | Minority Owned Products



Astraea
Astraea was forged where the evergreens give way to the rolling meadows, where the jagged mountain ranges drop into the sea, a love story from nature has to offer, Astraea’s award-winning gins transport you to the delivers distinguished, clean floral and herbaceous notes.
BIG NOSE KATE™
The extraordinary life of Maria Izabella Magdolna Horony, an affluent Hungarian American west through chance, rebellion, opportunity, and a deep curiosity in people and places, she would go on to be feared and revered everywhere as the inimitable Big Nose Kate. BIG NOSE KATE™ western whiskey is a firstof-its-kind blend of straight American Rye Whiskey and American Single Malt, to one of the greatest stories never told. Curious and satisfying, this groundbreaking blend captures essences of the West with bold spice, dry Earth, and
Birdie Brown
Birdie Brown Straight Wheat Whiskey is made from a mash of wheat, oats one of the few African American female homesteaders in Montana. She grew her own grains, distilled her own liquor, and served it up in her popular parlor
Group honors little-known African Americans who have made significant contributions to the world of Spirits through its high quality offerings.
Page 61 | Food & Beverage Magazine v March Issue 2024
Editor’s Top Pick | Minority Owned Products

Bollygood
Bollygood is the first Indian-inspired sparkling lemonade and limeade in North India from street carts to restaurants to home kitchens. Maxine, the founder, added a sparkling twist to this classic which is a new and exciting way to experience this beverage. Bollygood’s customers are both culture curious and health conscious. Bollygood is a better-for-you choice you can feel good about enjoying without sacrificing taste. It is 50 calories, only 7g added sugar, Nonand minority-owned company that spreads happiness and culture through our Indian-inspired sparkling beverages. Maxine has started in beverages with hopes to expand into new categories. Bollygood has launched into its first large chain of grocery stores, The Fresh Market. Bollygood is sweet, bubbly, unforgettable, just like India.

Corpse Reviver
Corpse Reviver, crafted by female founder Anna Zesbaugh, is a hydration libation crafted for every occasion and inspired by the traditional botanic beverage. This libation plays a simple role - to offer a better-for-you, non-alcoholic beverage with simple ingredients needed to bring the body back to life. Ease into enjoyment with benefits from the nutritionist-
zinc, potassium and sodium for recovery. Embark on a sensorial journey with Corpse Reviver’s variety pack
Danie’s Natural Juice Blends
sells all-natural cold-pressed juices and cleanses with no additives or flavorings. Its top-selling product is Mark’s Ginger Shot which has a potent blend of ginger, pineapple, and lemon with the option to add turmeric for an extra boost. The shot is formulated to kickstart the

Editor’s Top Pick | Minority Owned Products



De La Calle
With healthier lifestyles trending, many people have adopted moderate drinking habits by switching to low-abv or non-alcoholic options. The
bringing pineapple-based Mexican tepache to the U.S., is a non-alcoholic and low-sugar alternative to alcohol-based drinks that’s a delicious nonalc alternative. Fermented with pineapples and sweetened with turbinado sugar and other spices, and formulated based on the co-founder’s traditional
Desolas
The Salmiana agave, also known as the “green giant,” is cooked in aboveground ovens resulting in a mezcal with a fresh botanical aroma and gentle smoke. Its grassy, earthy and agave-forward character are a product of the Grill, BOHO house, among others.
Doughp
unique twist – it’s not just about the dough, but the empowering force behind female entrepreneurship in the culinary realm. Breaking barriers and shattering stereotypes, Kelsey has crafted a brand that not only satisfies the sweet tooth more than $100,000 to mental health & addiction recovery non-profits. Enter of resilience, creativity, and the sweet taste of success.
Page 63 | Food & Beverage Magazine v March Issue 2024
Editor’s Top Pick | Minority Owned Products

Dream Tea NYC
friendly way to create their tea blend successfully. The small-batch custom tea is changing how we enjoy sipping this age-old ritual to suit our taste buds. better than you. We’re here to help you take your ideal ingredients from dream blend to custom cup. Anney is available for interviews and can add a fresh perspective on creating a soothing tea ritual for 2024. She epitomizes the

Florida Pure Sea Salt
“Only the cleanest and best water is harvested to make the purest and finest tasting salts while protecting the waterways and its creatures.” She makes her salts to enhance the food we make and enjoy with family and friends. In addition to natural salts, Maureen makes several infused salts, garlic being the most popular. There’s hand-harvested, small batch and 100% pure, and are terrific to use in cooking or as finishing salts on dishes, and even on the rim of to Equality Florida. This non-profit organization is the largest civil rights organization dedicated to securing full equality for Florida’s
El Naranjo
Owned by Chef Iliana de la Vega and her husband, Ernesto Torrealba, El Naranjo’s World-Famous 7 Chile Salsa Macha is made in-house at El Naranjo Restaurant & Bar in Austin, TX. The condiment consists of chiles, oil and seeds. The restaurant also sells pumpkin seed salsa macha and sesame seed salsa macha. The restaurant packages and ships nationwide orders weekly.

March Issue 2024 v Food & Beverage Magazine | Page 64
Editor’s Top Pick | Minority Owned Products



FUZZBUTT Premium Vodka
in mind! Founder Linda Schurr named the brand in tribute to her late good boy Vodka donates 50% of its profits to animal rescue charities making each cheers a liquid tribute to Cody and all pups. Charities supported through
Kothe still using the highest quality non-GMO corn. With 18 plates used in the fractionating columns, it is actually distilled 20 times once it finally makes its way out of the condenser. This makes it incredibly pure with a perfectly clean and neutral finish that is smooth enough to sip chilled, over the rocks, or with your own favorite vodka cocktail.
gimMe
Growing up in central Seoul, Annie Chun never ate packaged seaweed. Instead, her mother would dry, roast, and make it from scratch at home. Wanting Americans to experience the snack the same way she did as a child,
& K and iodine. What’s more, each 10g pack is equal to a serving of veggies! These umami rich snacks are roasted to light and crispy perfection.
GOODONYA
provide an approachable solution to hydration. After years spent as a high-
direct-to-consumer subscribers, and 10,000 glasses are poured each year
Certified Glyphosate-Free hydration powder in the world, made with six simple ingredients straight from nature, such as lemon, coconut, and Himalayan pink
1g of sugar per serving, with no added sugar and no artificial or so called “natural” flavors. It tastes like light, refreshing lemonade and is available in
Page 65 | Food & Beverage Magazine v March Issue 2024
Editor’s Top Pick | Minority Owned Products

GoodSAM
Available at Sprouts, Whole Foods Market, Erewhon, and Thrive Market these indulgent and crunchy chocolate-covered nuts are layers of regenerative joy. Organically grown and sourced in Ghana and Kenya, GoodSAM’s Chocolate Covered Macadamia Nuts support small regenerative farms, biodiversity, fair wages, fair employee benefits, and indirect jobs that aid in poverty alleviation through capacity building and structural change. GoodSAM’s products include various chocolate bars, chocolate chips, nuts, coffee, candy-coated nuts, and more. All products in the GoodSAM line are direct trade, non-GMO, vegan, and gluten-free, and are grown using regenerative farming techniques and preserving indigenous and smallholder farmer wisdom.

Grüvi
Grüvi is an award-winning line of non-alcoholic social beverages from co-founder Anika Sawni, offering craft beer and wine for a hangover-free tomorrow. Grüvi is trailblazing a new way to live and socialize with alcoholfree beverages that make every moment more Grüvi. Grüvi’s Non-Alcoholic Sangria won a Gold Medal at the silver medals at IWSC and International Alcohol-Free awards, being recognized as one of the best non-alcoholic wines globally The Sangria is the perfect combination of fruit and spice with bright notes of blood orange, red currant and blueberry.
Happy Wolf
Happy Wolf is a new brand of wildly simple snack bars, founded by a busy mom. Their nut-free fridge-fresh bars are made with the simplest possible whole-food ingredients, sweetened with only dates and honey. The Chocolate Chip bars are made with datesweetened chocolate chips, delivering the rich flavor of a chocolate brownie, without the sugar crash. And unlike other ultra-processed bars in the grocery store, there are no weird powders, preservatives, additives, artificial or “natural” flavors…only real, whole ingredients you would use in your own kitchen. They’re school safe, allergy-friendly and will keep you satisfied and energized throughout the day.

March Issue 2024 v Food & Beverage Magazine | Page 66
Editor’s Top Pick | Minority Owned Products

500+
5,000+
4
60






Page 67 | Food & Beverage Magazine v March Issue 2024 JULY 14 -15, 2024 JULY 14 -15, 2024 S A N A N T O N I O , T X SAN ANTONIO, TX
Exhibit Booths
Owner/Operators
State Food Show in US
Largest
Education Stages
Speakers Industry Bootcamp (7/13/24) T E X A S TEXAS R E S T A U R A N TRESTAURANT S H O W SHOW The Texas Restaurant Association is the essential resource providing advocacy, education, and benefits to advance the restaurant and food service industry in the State of Texas. TXRESTAURANTSHOW.COM/ATTEND CLAIM FREE BADGE WITH CODE FBM24




Holidaily Brewing Company
Holidaily Brewing Company is the passion project of Karen Hertz, a craft beer enthusiast with an appetite for living life to its fullest. Having survived both melanoma and thyroid cancers, Karen adopted a gluten-free diet as part of her treatment. This lifestyle change, while essential for her health, posed a challenge for her love of beer and social activities. Faced with limited options in the gluten-free beer market, Karen felt compelled to create a solution. Enter Holidaily Brewing Company, a company committed to crafting exceptionaltasting gluten-free beer. Rooted in Karen’s dedication to health, happiness, and the celebration of life, Holidaily Brewing Company was born out of a desire to provide flavorful options for beer enthusiasts with dietary restrictions.

Holidaily Brewing Company is a 100% certified, dedicated, gluten-free brewery; one of only 17 in the United States, and the only certified womanowned brewery in the United States.
Hotel Tango
Hotel Tango is a veteran-owned and operated distillery in Indianapolis, Indiana owned by husband and wife Travis & Hilary Barnes. To honor their founder, Travis Barnes’ military service, the distillery’s name was made using the nato-phonetic alphabet, Hotel for Hilary and Tango for Travis. The company was born not only out of their founders’ passion for distilling,
welcoming to all comers who want to have a good time while enjoying high-quality spirits. Hotel Tango crafts 10 spirits with
Hot N Saucy
Featured on Season 18 of Hot Ones and Lizzo’s favorite hot sauce, this flavor packed sauce tastes like when the Thanksgiving collards touch everything else on your plate. This potlikker-flavored hot sauce made with one of the world’s hottest peppers will take your next meal out of the stratosphere with heat and FLAVOR! Created in small batches by chef Samantha Allonce, her six all-natural blends are mouth-watering and made with the experience restaurants. She puts flavor before the heat and caters to Americans’ rising need for the heat! With culture’s recipes and combines unique ingredients we don’t usually see together in hot sauces, like pepperoncini and honey.
Through it all, they have remained committed to delivering on

March Issue 2024 v Food & Beverage Magazine | Page 68
Editor’s Top Pick | Minority Owned Products



Innovatus
barriers and become a trailblazer in the Napa Valley wine industry. Her wine brand, INNOVATUS, epitomizes her dedication to innovation, seamlessly intertwining traditional and modern techniques that captivate palates Sparkling stands out. Crafted from the rare Napa Valley grape, Viognier, it is delicately balanced and brimming with flavors that are both full-bodied and refreshing. Utilizing the traditional Champagne method, this sparkling wine boasts complexity, effervescence, and a distinctive flavor profile, revealing delightful hints of citrus and green apple. Amassing acclaim from industry
quo, embodying resilience and innovation in the heart of Napa Valley.
Kankitsu Labo
KANKITSU LABO launched with the mission to become the bridge connecting with the US by assisting the growth of community farmers and manufacturers
Sudachi is commonly mistaken as lime, but has higher juice content. They’re fish, cocktails. Sudachis are finely pressed from the sides to emulate hand squeezing to control the amount of oil and to keep consistent purity. The cocktails and mocktails, and more!
Kapowder
your skin glow, from the inside out. Crafted only with premium, vegan and you need in a single scoop. Bid farewell to tablets that take ages to absorb, and get your daily intake of nutrients instantly. Tastes like citrus with a dash of green tea and features ingredients your skin will love, including Matcha, Acai
Page 69 | Food & Beverage Magazine v March Issue 2024
Editor’s Top Pick | Minority Owned Products

LALO
are revolutionizing the spirits landscape with their commitment to crafting an unmatched blanco tequila experience. As minority-owned entrepreneurs, they embarked on a quest to redefine tequila, placing authenticity and purity at the forefront. Originating in Guadalajara, their journey started humbly, producing small batches for intimate circles, yet swiftly gained widespread acclaim for its extraordinary flavor and unadulterated essence. LALO blanco embodies the pinnacle of tequila craftsmanship, meticulously distilled twice to perfection without the need for barrels or additives. Their process centers on handpicking

pay homage to the essence of agave by adhering to a minimalist approach, incorporating only agave, yeast, and water in their blanco creation. Through their steadfast commitment to quality and heritage, LALO Tequila shines as a beacon of excellence in the spirits industry.
Luji’s Chocolate
crafted and packaged from bean to bar in West Africa and made with unique ingredients from the region. When you purchase a Luji’s bar, they’ll deliver cocoa tree seedlings to creating the finest chocolate that celebrates the unique flavors of West Africa, Luji’s Chocolate mission is to blend exquisite taste with authentic regional ingredients, crafting a chocolate experience that’s truly West African at heart. In addition to creating mouthwatering chocolate, they are also adding value to the local economy where our chocolate comes from. The Luji’s sampler set includes 4
Lobos 1707
Lobos 1707 Tequila & Mezcal is an independent spirits producer that blends heritage and innovation. Inspired by rich family traditions, Founder and Chief Creative backing from legendary athlete and cultural icon LeBron premium award-winning offerings infused with history, the finest ingredients, Lobos 1707’s portfolio is all natural and gluten-free, with zero color or flavor additives. Made with 100% Blue Weber Agave, then aged in American Sherry wine barrels using the Solera method for unique and elevated flavor profiles. Lobos 1707 is Influenced by both old and new world techniques, harvested, distilled
Spicy Suya. All of the bars are single origin & 100% made in West Africa. Each flavor is in beautifully designed packaging that puts the Luji’s mission at the very center. producing over 70% of the global supply, only a fraction of the chocolate is actually made there? That’s where Luji’s Chocolate stands apart. They are deeply rooted in the rich soils of West Africa, collaborating hand-in-hand with local farmers & local processors to cultivate their cocoa and make chocolate right in the heart where it all begins.

March Issue 2024 v Food & Beverage Magazine | Page 70
Editor’s Top Pick | Minority Owned Products



Made Simpli
by the minority and woman-led company Made Simpli, this innovative French press is redefining the coffee experience with its unique design. The Simpli
system, ensuring a smooth, rich cup of coffee without the mess traditionally associated with French presses. This design not only enhances the brewing process but also champions eco-conscious practices by facilitating cleanup and minimizing waste. Committed to making a difference, Made Simpli dedicates 10% of its profits to supporting communities in need, illustrating the company’s dedication to empowerment through innovation.
Melinda’s Hot Sauce
Melinda’s Hot Sauce stands as a beacon of excellence in the realm of minorityowned businesses, embodying the essence of cultural richness through its authentic and flavorful offerings. With a commitment to preserving traditional methods of hot sauce production, Melinda’s takes pride in crafting each bottle with love and care, using only the finest and freshest ingredients. Melinda’s mirrors the diversity within the minority community, particularly Latinx, offering a wide range of heat levels and flavors to cater to every palate. From mild and tangy to explosively spicy, there’s a perfect sauce for every taste preference. Melinda’s Hot Sauce not only celebrates its minority heritage but also showcases the entrepreneurial spirit and culinary expertise within the community. Through its dedication to delivering exceptional taste experiences, Melinda’s has carved a niche as a standout minority-owned brand in the competitive market.
Michele Foods
Founded by Michele Hoskins, Michele Foods is the first Black woman-owned syrup company, offering three delicious gourmet options made from secret family recipes dating back to the late 1800s. Hoskin’s great-great-great grandmother, America Washington, was a formerly enslaved person who developed a recipe for syrup out of churned butter, honey and cream as an alternative to molasses. This recipe is used today in the brand’s stand-out line, making it a “sweet family legacy in a bottle.” Michele Foods offers three flavors 40 years of “Good Over Everything” syrups.
Page 71 | Food & Beverage Magazine v March Issue 2024
Editor’s Top Pick | Minority Owned Products

The next step of your hospitality career starts here
Browse thousands of jobs from some of the industry's most prestigious companies

Search Jobs






Mingle
Mingle is a line of sparkling ready-to-drink craft mocktails, founded by Laura Taylor & now backed by Bethenny Frankel, which can be enjoyed solo or used as a premium mixer. Mingle strives to make everyone feel part of the party, whether or not you choose to drink, with its range of six sophisticated nonalc flavors, including Cranberry Cosmo. Imagine the clinking of glasses, the laughter of friends and the joy of celebration. Now, add a touch of cranberryinfused elegance to the mix. Cranberry Cosmo redefines what it means to celebrate. Bursting with the essence of tangy cranberries, balanced by a hint of citrusy sweetness, this non-alcoholic beverage mirrors the sophistication of a classic Cosmopolitan cocktail that’s perfect for relaxing after a long day, enjoying a casual evening with friends or celebrating a momentous occasion.
Mr Bing
Mr Bing’s goal is to make the most accessible, sustainable, and better-for-you East Asian Steet Sauces to celebrate an evolving “All-American” food culture. Mr Bing Chili Crisp, made from scratch since 2015, is constantly evolving to meet the dietary needs of their customers. The result was a punchy, crunchy, irresistible condiment and cooking ingredient that’s also non-GMO, Kosher, gluten free, free from 9 known allergens, and made without flavorings or preservatives. Mr Bing specializes in making accessible, clean-label sauces that are inspired by the street food of East Asia, and easy to love on virtually any cuisine. Their street sauces include Chili Crisp, Sriracha, Hot and Sticky Wing Sauce, with two more sauces launching in 2024. Mr Bing is a minority owned business and donates monthly to charities that support the Chinese communities that inspired the company.
Mud Australia
finish. Made of premium porcelain, its versatile, timeless shape can be used is available in 10 striking shades to complement any tablescape or season. These plates, along with Mud Australia’s other dinnerware, are microwave, oven, and dishwasher safe, for effortless prep and clean up, making them ideal for restaurants and home chefs alike.
Page 73 | Food & Beverage Magazine v March Issue 2024
Editor’s Top Pick | Minority Owned Products


Pari Foods
NoAlchCo
distinctive alcohol-removed wine brand for sophisticated and intentional consumers looking for quality, mindful indulgence, and a pleasurable drinking experience. Crafted with health in mind, NoAlchCo wines are low in calories, contain no added sugars, and boast a natural taste with no artificial flavor. NoAlchCo sources 100% California grapes for its wines, using traditional fermentation methods. The innovative spinning cone column technology is then employed for vacuum distillation, removing alcohol while preserving the
reintroduces natural flavors without the use of sugar or artificial additives. This Rose provides a crisp, mineral, and refreshing finish with hints of rose and strawberry. This non-alcoholic wine provides the flavor profile of a luxurious flavors, and has 20 calories.
Partake
when her daughter was diagnosed with multiple food everyone the ability to partake and share in life’s joys— big and small. The Black-owned, women-led company offers delicious, allergy-friendly cookies, baking mixes and pancake & waffle mixes that are certified gluten-free, nonGMO, vegan, and free of the top 9 allergens (wheat, tree
The products are made with better-for-you ingredients and offer a variety of new and nostalgic flavors that those with and without dietary restrictions can enjoy. With radical
organization that symbolizes a legacy of supplying the world’s longest and finest quality Basmati Rice across the United States. It developed its innovative new productRegal Harvest Smoked Basmati Rice. This Basmati Rice is grown in the foothills of the Himalayas, aged for 2 years and smoked with natural willow wood. Smoking gives an appetizing twist with its unique smoky aroma and earthy, toasty flavor. It complements all cuisines. It
Smoked Basmati Rice to new buyers who are seeking revolutionary new flavors to upgrade their offerings or menus and seeking better Basmati Rice for higher yields and profits.

Editor’s Top Pick | Minority Owned Products


YOLO Spirits
a mixture of the finest American yellow and white sweet corn. “The Classic” carries vanilla undertones, with hints of white peppercorn giving it a velvety rich finish, which is elegant on the rocks. The biggest plus is that it’s gluten-free, GMO free, 2015.
Zeal
Take a sip of this all-in-one nutritional drink mix to experience essential nutrients and more through a bold and richly refreshing Bold Grape flavor. Available in a bag of 10 single-serving packets – gluten free and vegan - making this the perfect travel companion. Zeal for Life contains over 56 whole food nutrients that includes over 120 vitamins*, minerals and antioxidants. Zeal has been clinically shown to reduce stress and increase productivity while making you feel vibrant, focused, calm and confident. Zeal’s natural source of clean energy can provide a boost of consistent and stable, long-lasting energy throughout your travels.
Page 75 | Food & Beverage Magazine v March Issue 2024
Editor’s Top Pick | Minority Owned Products




Phenomenal Spirits
Sudhir immigrated to the US from India with barely $400 in his pocket. After first establishing a presence in the tech industry, Sudhir pivoted to pursue his passion of creating exceptionally high-quality brands that fill untapped opportunities in the craft spirits category. Literally, built from scratch,
brands that are increasingly peaking consumer curiosity. The success of both brands has fueled further expansion to 19 states and provided the launch pad needed to take these two multi-award-winning craft brands to the global markets. The company operates its own blending facility in Virginia Beach and is fully functional, allowing the team to control quality and consistency along with all aspects of product development. Sudhir’s is all set to scale throughout the US and on the world stage.
Pipcorn
Martin and his wife, Teresa Tsou, and became a Shark Tank success story
“Oprah’s Favorite Things’’ three times and is beloved by celebrities, families, and on-the-go snackers across the nation.
Poi Dog Sauces
nominated journalist, and artist. Inspired by her childhood split between Hawai’i and Hong Kong, and eventual transition into the contiguous states, Aranita confronts the nuances of her identity in each facet of her life through
Noelani, named after founder Chef Kiki Aranita’s younger sister, available now on most tables in Hawai’i, nestled next to the shoyu. We say “chili peppah water over everything” and “everything” refers to rice, meats, macaroni
perfect seasoning for Hawaiian style plate lunches, poke bowls, raw oysters, margaritas, mocktails, and more. Vegan and gluten free.
Page 77 | Food & Beverage Magazine v March Issue 2024
Editor’s Top Pick | Minority Owned Products

Quiet Sun
Add a touch of elegance to your table setting and feel good while doing it with landscape, this tablecloth was ethically handcrafted by environmentalist fair wages, safe jobs, and the goal of self-reliance and employs women poor, or landless without another source of income. So not only will this table runner elevate your next meal at-home, but it helps to support many of the

Sipwell Wine Company
Sipwell Wine Company is a female-founded company based in Southern California that makes vibrant, award-winning canned wine. Owner, Hilary Cocalis is passionate about the planet which is why the singleserve, aluminum cans are infinitely recyclable and all of the wine is sourced from organically and sustainably farmed grapes in California’s Central Coast. Launched in May 2021, Sipwell’s four award-winning wines are available for sale at retail and online, shipped in packages of 6 or 12. Tiny Victories Sparkling White Wine is the first and only canned wine to make Wine Enthusiast’s Top 100 list. A blend of Chardonnay and apple, and chamomile. The bubbles bring out some biscuit-y notes, balancing out its refreshing tartness.
Tenango Rum
to reshape the world’s perception of rum with her brandgrandmother, a pioneering woman distiller in the 1920’s, Tenango is an homage to family, good times, and the female entrepreneurial spirit The rum also aims to provide a sustainable income for Guatemalan communities via employing women and craftspeople to hand-make the vibrant covers that adorn each bottle. The traditional Mayan sheaths are woven on a traditional foot loom by a Guatemalan Kik’che’ Women’s co-op that specializes in this cultural practice. Tenango features rich notes of cocoa, banana, coffee, almond, and tropical fruits, which seamlessly dance with the whiskey notes imparted by the second use barrel, adding flavors of butterscotch and caramel, making this the perfect rum for whiskey lovers. This mission-driven spirit is available online for nationwide shipping.

March Issue 2024 v Food & Beverage Magazine | Page 78
Editor’s Top Pick | Minority Owned Products



The Blending Lab Winery
The Wine Blending Kit from The Blending Lab Winery provides a wonderful experience for wine enthusiasts to jump into one of the most exciting functions of the winemaking process – wine blending trials. Skip buying “red blends” at the store and use this kit to make a one-of-a-kind, personalized wine blend. The Wine Blending Kit provides the tools– beakers, graduated cylinders and more, process– booklet and instructional videos, and wine necessary to create a personalized wine blend using three single varietals that were created specifically for this hands-on experience. There is no better way to learn about the basic science of wine and develop new vocabulary to be able to understand and describe wine preferences more simply. The Blending Lab’s Wine Blending Kit is one of the most unique and fun wine drinking experiences available and will change the way wine enthusiasts think about and drink wine.
Tipsy Scoop™
Melissa Tavss started Tipsy Scoop™ in 2014, inspired by her great-greatgreat grandfather who made ice cream at home and sold it in a push cart. Following in the ice cream tradition, she began to experiment with putting a
contemporary cocktails, these ice creams are ready to be devoured straight from the pint, scooped into a sundae or blended into a malt-ini milkshake. Tipsy Scoop’s intoxicating ice creams are not merely flavored with liquor, but in fact contain up to 5% alcohol by volume.
Tom Bullock’s
Tom Bullock’s Burnt Orange Bourbon is smooth, 4 years old, bottled in Kentucky and kissed with the sweet, smoky, caramelized grace of burnt orange rind. Tom Bullock, an esteemed bartender, literally wrote the book on cocktails. Consider him The Original Tastemaker. In 1917 he became the first African-American to publish a cocktail book, The Ideal Bartender. With African Americans who have made significant contributions to the world of Spirits through its high quality offerings.
Page 79 | Food & Beverage Magazine v March Issue 2024
Editor’s Top Pick | Minority Owned Products

Two Fish Foods
Two Crab Shack could have been among the statistics. Instead, it resulted in starting a consumer goods business that has allowed Curtis’s food to reach thousands of seafood boil devotees nationwide. With indoor dining closed and without a carryout system in place, Curtis took to her kitchen, combining in an easy-to-use, frozen package fans could keep in their freezers and enjoy
Foods’ shrimp and snow crab seafood boil bags are available in the freezer section at thousands of grocery stores nationwide.

wildwonder
Growing up in China, founder Rosa Li’s grandmother brewed healing tonics with a symphony of wild herbs and botanicals. They worked wonders, soothing her stomach and lifting her spirits. wildwonder is a reimagination of Rosa’s heritage, rooted in Eastern herbalism with flavors as fresh as a California produce stand. Every recipe combines gut healing superfoods and botanicals with whimsical flavors to make gut health as easy as cracking open a can. The newest with a twist, combining pineapple, zesty lime, and tangerine juice with Szechuan peppercorn for a complex, yet nostalgic flavor with a warm hint of spice. All wildwonder beverages are gluten-free, non-GMO, one billion live probiotics and five grams of prebiotic
Five percent of profits from every drink goes towards empowering women and marginalized communities.
March Issue 2024 v Food & Beverage Magazine | Page 80
Editor’s Top Pick | Minority Owned Products
Embrace the power of great flour with pure organic flour and semolina from Europe and turn your next pasta, pizza, pane or dolce into a knockout dish. They're the secret at the heart of premium pasta, bread and baked goods and the ingredients of choice for chefs and home bakers who prize quality and consistency for everything they make.






filPURE FLOUR filEUROPE ORGANIC &SUSTAINABLE FLOUR EXPERIENCE
POWER
FLOUR
taste
difference visit us at Booth #2009 in Hall B Natural Products Expo West - Anaheim - 14 / 16 March 2024 For more information and recipes visit www.pureflourfromeurope.eu ffift\ffilTALMOPA n - CO-FUNDEDBYTHE EUROPEANUNION THEEUROPEANUNIONSUPPORTS CAMPAIGNSTHATPROMOTEHIGH QUALITYAGRICULTURALPRODUCTS. Views andopinions eiressed are howeverthose of the authorls) on�and do not necessarilyreflectthose of theEuropean Union or the Fll f1'�a @pureflourfromeuropeca www.pureflourfromeurope.eu European Research xeculive Agency (REA). Neither the European nion nor the granting authority can be held responsible for them. 0 OW US OnLJ:J� @pureflourfromeuropeusa
To
the









































Lightly Smoked launches
INDUSTRY LEADERS • TRENDS • BEVERAGE • CUISINE • CHEF • RESTAURANT • HOSPITALITY























































COVER IMAGE
Ducktrap by MOWI USA
PUBLISHER
MICHAEL POLITZ Michael@fb101.com
DIRECTOR & EDITOR-IN-CHIEF LAUREN KANE Lauren.Kane@fbmagazine.com
SOCIAL MEDIA CONTENT MANAGER
SHELBY POLITZ Shelby.Politz@fbmagazine.co
DIRECTOR OF PROGRAMMATIC SALES BARB ROGERS Programmatic@fbmagazine.com
ACCOUNT MANAGERS
LENORE O’MEARA Lenore.Omeara@fbmagazine.co
DAVID JACOBS David.Jacobs@fbmagazine.co
AUSTIN VALDEZ Austin.Valdez@fbmagazine.co
SUSAN GOLD Susan.Gold@fbmagazine.com
CONTRIBUTING EDITORS
MICHAEL POLITZ
STEPHANIE BLITZ
CONTRIBUTING WRITERS
LAUREN MCINDOO
LENORE O’MEARA
DAVID JACOBS
SUSAN GOLD
SHELBY POLITZ
ETHAN BALSAMO
AUSTIN VALDEZ
RYAN SLATTERY
We honor and remember the support of Chef Kerry Simon, Gary Cantor, Robin Leach, Chef Paul Prudhomme, & Gary Coles
ISSUE 2024
MARCH
Food & Beverage Magazine® is owned and published electronically by Beautiful People, LLC. Copyright 1995-2016 Beautiful People LLC. All rights reserved. Food & Beverage Magazine® and distinctive logo are trademarks owned by Beautiful People, LLC. “fb101.com” is a trademark of Beautiful People, LLC. No part of this electronic magazine may be reproduced without the written consent of Food & Beverage Magazine. Requests for permission should be directed to: Lauren.Kane@fbmagazine.com. The information contained has been provided by such individual, event organizers or organizations. The opinion expressed in each article is the opinion of its author, organization or public relation firm. Food & Beverage Magazine is not affiliated with any other food and beverage or hospitality publication.

Page 3 | March Issue 2024 v Food & Beverage Magazine

March Issue 2024 v Food & Beverage Magazine | Page 4
A NEW SMOKED SEAFOOD PRODUCT GUARANTEED TO BE A MAINE ATTRACTION
created a ready-to-cook product infused with natural smoke
business units globally, as well as infrastructure sharing within
This new product platform that invites consumers to enjoy a light, smoky salmon designed to be cooked the way of their choosing. Every bite is the perfect combination of freshness
salmon filets skillfully seasoned and smoked with a unique blend of maple, oak, cherry and applewoods. Ready for the oven, pan or grill — you can’t go wrong.
The initial launch included fresh, pre-packed portions for retail shoppers. However, as the product has continued its expansion, brands. The idea initially came about from some new product
put their own spin on this innovative concept and, with the machines to successfully offer the product in pre-packed form.
completely satisfying to the US consumer palate.
in late 2021 and continued to grow at an impressive rate. In
American spokesman, and host of TLC’s Ultimate Cake Off.
very beginning, having recognized the originality of the product and the opportunity that exists to appeal to both mainstream consumers and food service brands.

Page 5 | March Issue 2024 v Food & Beverage Magazine

March Issue 2024 v Food & Beverage Magazine | Page 6
“LIGHTLY SMOKED WILL BE A NEW PRODUCT FOR CONSUMERS TO TEST THEIR ADVENTUROUS CULINARY SPIRIT,” SAID DURAN. “I BELIEVE THIS IS THE IDEAL SALMON EXPERIENCE FOR HOUSEHOLDS AS IT IS BIG ON FLAVOR AND TAKES LITTLE EFFORT TO COOK. ADDITIONALLY, THERE IS CURRENTLY NOTHING LIKE IT ON RESTAURANT MENUS.”



Page 7 | March Issue 2024 v Food & Beverage Magazine
Lightly Smoked is a meal that cooks in just a breeze and there is no need to add too much seasonings
that are already blended into the salmon make for an extremely enjoyable eating experience. Today, this delicacy is sold at five macro retail chains nationwide as well as via e-commerce. The introduction of this new product is an important
expertly infused, easy to make, go-to salmon for any occasion.
Since its humble beginnings over 40 years ago,
Fitzgerald found a spot of land on the Kendall Brook in Lincolnville, Maine. He decided to experiment with smoking some of his trout and eventually built
the smokehouse and started smoking trout. Selling his smoked trout to local markets, he achieved an amazing amount of success.


March Issue 2024 v Food & Beverage Magazine | Page 8
wholesome smoked seafood using traditional European smoking methods. Little did he know, this was the start of a brand that would one day become known as one of the best smoked seafood in the industry. What started with two workers and a dream has scale 125,000 sq. ft. smoked seafood campus. Today all four of the smoked seafood standard and exceeding the expectations of taste buds nationwide.
With all the excitement building around Lightly Smoked, it’s important to mention that it is just one of an entire line of impressive
all available for purchase at a store near you.

products here.


“Food is our common ground, a universal experience.”


PR%F Awards Celebrates its 5th Year of Competition
By Michele Tell









56 %
awards celebrates its 5th year of competition
PR%F
MASKED
PR%F
Awards is a rating competition platform for spirits, wine, and beverages to be evaluated for taste and design with the utmost integrity, credibility, and inspiration.
That is the key element of why ALL of the PR%F Awards judges are all beverage buyers—not only to highlight and find the latest in trending spirits but also to have an opportunity to put those new brands on shelves and into consumers' hands. Our judges assemble annually in a private two-day PR%F Awards competition where they sample, discuss, and rate brands from across the US and internationally. The chatter among our judges discusses trends, buying habits, spending habits, price points, and, mostly, taste. Each brings a buyer’s perspective to the competition and what their customers drink and prefer.
This year, it was unanimous that our bottles, the designs, the quality of craftsmanship of the bottles, the retro cool different sizes of ready-to-drink cans, and the overall theme of many new brands were eclectic and exciting.
UNMASKED
The totalpackage competition
Our judges come from all walks of the industry. Highlighting the PR%F Awards is Delta Sky Club® and Delta Airlines, our signature partner for the past five years, with growing Sky Clubs in Los Angeles, Kansas City, Minneapolis, JFK, Boston, Newark, Los Angeles and Haneda, Japan. Additional spotlight establishments include Bashas' and AJ's Fine Foods in Arizona, recently acquired by Raley's and the world’s biggest big box chain of all, Walmart. Specs in Texas, Liquor World, dozens of distributors, Sahadi Liquor in Brooklyn, Boyd Gaming, and Palms Casino Resort also represented at our competition this year, just to name a few.
At PR%F Awards, beverage brands are judged separately for two different types of competitions during a two-day private event. Brands are scored against a 100-point rating program. So, we like to call it “brand against itself,” unlike other competitions, allowing us to add a myriad of unique categories each year.
Our judges come to the PR%F awards for one reason—to be introduced to the newest spirits, wine, and beverages on the market—and to have a private experience
% Magazine P %F the
The coveted double-blind tasting competition
PR%F awards celebrates its 5th year of competition
% PR%F awards celebrates its 5th year of competition
to taste and evaluate hundreds and hundreds of brands with peers to discuss trends, pricing, taste and appeal with like-minded buyers from different areas of the United States.
Our judges, all buyers, are awestruck with the creativity of the brands that cross their palates each year. Our continued growth in vodka, tequila, and whiskey, the array of RTDs (unique flavors), and the burgeoning alcohol-free and coffee-based beverage space were amongst the chatter at the 2023 PR%F Awards. This year, the noted varietals that sparked in more entries included añejos, flavored tequilas and moonshines, brandies, Mezcals, rums and gin, wines of exceptional varietals, and so much more. This year, our competition sported two complete rounds of cognac, more than any year of this competition.
Each brand automatically gets entered into two separate and different competitions— PR%F Awards Masked! (double-blind) and PR%F Awards Unmasked - The Total Package, a combination of taste, packaging, logo, and design. This allows all our entrants to win two medals based on a single entry fee.
All spirit entries are judged in The NEAT Glass, the official judging glass for serious spirit competitions and the first and only sensory science-designed vessel engineered to deliver all aromas to the nose for complete, accurate evaluation.
A special accolade is presented to womenowned brands that have busted through the glass ceiling and made a mark as owners, distillers, creators, and more. Kosher brands (both spirits and wine) entered this year with fury, and each is also presented with a special Kosher-certified accolade upon entering. Both
awards are intended to be used for marketing and letting the marketplace know what sets them apart from the rest while promoting their bottles and cans.
In 2024, we are debuting our Veteran Owned Award. All veteran-owned brands, will receive a specialty award to highlight their commitment to our country. The PR%F Awards organization thanks these strong men and women for their dedication and service to keep us safe at home.
Heading into our third year of online distribution is PR%F the Magazine, a beverage specialty digizine designed to enhance awareness and uncover trends in the beverage industry in line with our signature media partner Food and Beverage Magazine, leading in the hospitality, food, and beverage industries for the past 20+ years and boasting over 14 million readers.
We built the PR%F Awards with a marketing mindset to help new and emerging brands get a chance to be placed on a public shelf, offer guidance, accolades, a magazine, and wordof-mouth social media to build awareness… and dreams. Congratulations to our winning brands. We look forward to seeing your growth throughout the year.
Our registration is open. Enter your brand today at www.proofawards.com
PR%F awards celebrates its 5th year of competition










% Magazine P %F the








 % PR%F awards celebrates its 5th year of competition
% PR%F awards celebrates its 5th year of competition







A Special Thank You to This Year's Judges*
Gemma Acheson
Johnson Brothers
Edward Allen
Carnival Cruise Line
Chris Anderson Rustic House
Eve Bushman UNLV - Wine
Nicole Canfeld
Palms Casino Resort
Brittany Chardin
Movers & Shakers
Delta Sky Club®
Bobby Cheng Food & Beverage Consultant
Christine Crnek
The NEAT Glass
Ken Dayton
Pacifc Edge Wine & Spirits
Daniel de Anda Fast
Horizon Event Solutions
Aaron "Doc" DeFeo
Little Rituals, Marriot Phoenix
Cesar deMark
Spec's Fine Wine & Spirits
Jena Domingue
UrbanVino; WineDirect
Michael Giambrone
Raise the Bar
Sean Hackney Bar Beverages
Karen Harling
Walmart
Ken Heck
Chinglish
Kitty Heck
Chinglish
Lou Hirsch
Breakthru Beverage
Alice Itsell
Basha's, Raley's, AJ's Fine Foods
Steve Jabour Spec's Fine Wines & Spirits
Gwendolyn Jackson
Liquid Distributors, Atlanta
Tylor Kezar
S Bar Las Vegas
Bobby Kryger
Al's Garage Sports & Gaming
Matthew-Lorén Lindsey
Hire A Sommelier.com
West Coast Beverages
Brian McCullough
Spec's Fine Wine & Spirits
TJ McNally
Boyd Gaming
Margaret McSweeney Kitchen Chat Podcast Host
Chris Motley
Liquor World
Caroline Navish
Sahadi Spirits, Brooklyn NY
John Oliver
Breakthru Beverage
Kenny Okada
Lotus of Siam
Kristine Reynolds
Palms Casino Resort
Chris Rosano
Palms Casino Resort
Matthew Rose
Partage
Roy Saunders
T-Bones Chophouse, Red Rocks Resort
Tucker St. John
Esther's Kitchen
Abe Taylor
Downtown Hospitality Group
Greg Van Stone
Palms Casino Resort
Danny Wedge
John Cutter Tavern, Al's Garage, Rustic House
Magazine P %F the %
*By request, not all judges are named above.
a special thank you to this year's judges
























































































































































































 said Keith Schroeder, CEO of Novipax.
said Keith Schroeder, CEO of Novipax.




































 By Ryan Slattery
By Ryan Slattery








 By Kersten Rettig
By Kersten Rettig
















































































































































































 % PR%F awards celebrates its 5th year of competition
% PR%F awards celebrates its 5th year of competition















